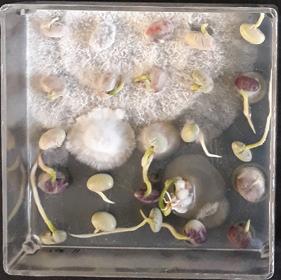

Diretas
das galhas em arroz irrigado Manejo do bicho-mineiro

cafeeiro
de doenças da soja em MS
semeadura
Anomalia
soja
solo
Ajustes baseados
laudo técnico aumentam a fertilidade


Coluna




das galhas em arroz irrigado Manejo do bicho-mineiro

cafeeiro
de doenças da soja em MS
semeadura
Anomalia
soja
solo
Ajustes baseados
laudo técnico aumentam a fertilidade


Coluna

Anna Malmskov assumiu a posição de Global Digital Commerce Strategy Lead. Trabalhará a partir de Saint Louis, Estados Unidos. Ela enfatiza o esforço da empresa para levar aos agricultores melhores novidades possíveis em ter mos de tecnologia.

A ICL lançou no Brasil o fertilizante de solo PotashpluS. O produto, do Reino Unido, traz em sua composição 50% de polysulphate em pó e 50% de cloreto de potássio em pó em um úni co grânulo. “Em razão de as concentrações de nutrientes estarem de forma equilibrada, ocor re um efeito sinérgico na absorção”, explicou o gerente de Fertilizantes de Solo da ICL, Thiago Sylvestre.

A Corteva Agriscience assinou con trato definitivo para adquirir a Symborg, especialista em tecnologias microbio lógicas. A Symborg possui portfólio diversificado, pipeline de biocontrole emergente e uma base de funcionários qualificados. "Trata-se de passo impor tante para acelerar o desenvolvimento de um portfólio de produtos biológicos de primeira classe", explicou Robert King, da Corteva.

A Staphyt, empresa francesa de serviços regulatórios e consultoria em pesquisa e desenvolvimento, concluiu a aquisição da Phytus, empresa de con sultoria e serviços na área de pesquisa e desenvolvimento de produtos do Brasil. A Phytus junta-se à estrutura da Staphyt Brasil, que passa a oferecer três centros de pesquisas. Ficam no Rio Grande do Sul, Goiás e São Paulo.
No dia 3 de setembro, um grupo de ex-colaboradores das empresas Hokko e Arysta se reuniu em Vinhedo (SP) para uma confraternização. Os amigos da “ve lha-guarda” relembraram fatos e histórias que marcaram suas trajetórias dentro das empresas. Muitos ainda atuantes no mer cado sabem a importância de fortalecer laços em momentos presenciais de grande valor humano, indo além do digital.


A Tradecorp inaugurou seu primeiro "Centro Global de Pes quisa e Inovação em Biossoluções" no Brasil. Está localizado em Hortolândia (SP). Rafael Leiria, diretor de Operações da Tradecorp do Brasil, explica que o centro de pesquisas tem como principal objetivo desenvolver biossoluções inovadoras a partir de micro -organismos como fungos e bactérias, capazes de contribuir para uma agricultura mais produtiva e sustentável. A infraestrutura está sob a gestão de Johana Rincones Pérez.
A Sumitomo Chemical apresentou sua plataforma completa no Congresso Brasilei ro de Sementes. A gerente de Tratamento de Sementes da empresa, Suellen Drumond, destacou o lançamento dos produtos Loyal ty Bio, EndoFuse e EndoMaxx. “O Loyalty Bio tem alto rendimento com formulação líquida de baixa dose, sendo compatível com fungicidas, inseticidas e inoculantes”, ressaltou.



O coordenador de Marketing do Se edGrowth da Bayer, Bruno Vilarino, desta cou o novo fungicida para tratamento de sementes, Redigo, durante o Congresso Brasileiro de Sementes. Com modo de ação exclusivo, que vem para proteger o sistema radicular e do colmo em relação aos principais patógenos das culturas de trigo, milho, soja e algodão. O produto contribui para que a planta possa expres sar o seu máximo potencial produtivo.

A Basf tem enfati zado sua plataforma de sementes. Está dividida em quatro marcas. Pa ra a soja, a de licencia mento Soytech; a marca verticalizada Credenz; a de arroz Lidero; e a de algodão FiberMax. To das foram sucesso no Congresso Brasileiro de Sementes.
A Rizobacter desempenhou impor tante papel no Congresso Brasileiro de Sementes. Apresentou a palestra “A ino culação no TSI: vantagens e desafios" e lançou o biofungicida Rizoderma TSI para tratamento de sementes na indústria. O Rizoderma TSI é o primeiro e único fungi cida microbiológico no Brasil à base de um Trichoderma afroharzianum com cepa ex clusiva da Rizobacter. A empresa também destacou o inoculante Rizofos.
A Ihara apresentou no Congresso Bra sileiro de Sementes duas tecnologias. O Pureza N é focado no segmento de pasta gens. É fungicida voltado para o tratamen to de sementes de forrageira, que con trola os principais patógenos da cultura. Para os demais cultivos, como soja, feijão, amendoim e algodão, a Ihara apresentou o Convence FS. Possui amplo espectro de ação, fácil aplicação e manuseio.


A UPL marcou presença no Congresso Brasileiro de Sementes com destaque para o fungicida Vitavax-Thiram 200 SC. Consiste em produto de ação multicultura e multialvo. É o primeiro e único tratamento de sementes contendo carboxamida e ação multissítio do mercado. Também apresentou o Start, que oferece proteção desde o início do ciclo de cultivo. Composto por fipronil, combate as principais pragas em diversas culturas.

Nilson Meretti assume função comercial na Acadian do Brasil. É responsável pelo suporte técnico e comercial junto à Koppert e seus distribuidores no estado de São Paulo. Ele é agrônomo forma do na Faculdade de Agronomia Manuel Carlos Gonçalves. Iniciou sua trajetória profissional no segmento de agroquímicos na Hokko do Brasil, posteriormente Arysta Lifescience e, ultimamente, na UPL. A Acadian do Brasil é uma empresa do grupo canadense Acadian Plant Health, que oferece soluções para a agricultura através de tecnologia para aprimorar de maneira sustentável o vigor, crescimento e desenvolvimento das plantas.



Nosanos 1980, a espécie de nematoide Meloidogyne graminicola era considerada prejudicial em terras al tas. Entretanto, nas condições de lavouras irrigadas, não preocupava, embora estudos mostrassem sua sobrevivência nessas áreas.
Porém, na última safra, foram acompanhadas lavouras de arroz irrigado com danos de nematoide das galhas (Meloidogyne spp). Em todas as regiões orizícolas do estado do Rio Grande do Sul fo ram encontradas, na safra 2021/22, áreas atacadas pelo nematoi de. Em várias dessas áreas, foram coletadas amostras de plantas com as raízes e enviadas para análise e identificação. Os resulta dos mostram tratar-se da espécie M. graminicola. Essa espécie de nematoide tem preocupado devido ao aumento da população, ao maior número de lavouras irrigadas atacadas, à magnitude dos da nos causados e à pouca informação sobre o seu comportamento.
O nematoide geralmente ocorre em partes da lavoura (rebo leiras) e não de maneira uniforme, porém, nas últimas safras tem aumentado as áreas afetadas com a doença nas lavouras do Rio Grande do Sul. A sua disseminação é maior nas áreas ainda não irrigadas, visto que antes da irrigação há maior ataque ao sistema radicular das plantas, sendo a reprodução menor após a entrada da água.
Uma característica para a identificação do Meloidogyne é a presença de galhas, algumas com o aspecto de gancho ou cabo de guarda-chuva.
As galhas das pontas das raízes podem afetar o desenvolvimen to das plantas pela diminuição da absorção de água e nutrientes. Ocorre, consequentemente, estresse hídrico e nutritivo, provocan do os sintomas observados na parte aérea das plantas, como folhas amareladas, plantas com menor estatura e atraso no florescimento.
Como a doença tem alto fator de reprodução, a infecção ini cial das plantas é preocupante, pois nesse período as raízes são pequenas e mais facilmente afetadas. Como o efeito nas raízes não é visível, quando são observados sintomas na parte aérea das plantas, o dano já ocorreu.
A realização de amostragens, nas áreas das lavouras que têm apresentado os sintomas da ocorrência do nematoide, é muito importante. O número de amostras coletadas auxilia na determi nação da doença, pois, quanto mais áreas monitoradas, mais fácil será identificar as partes da lavoura atacadas.
Por isso, recomenda-se a coleta de 20 ou mais amostras, prin cipalmente nas áreas com sintomas de plantas amareladas e com menor estatura. As avaliações são realizadas arrancando-se as plantas com parte aérea e raízes. As plantas podem ser colocadas em um balde com água ou na própria lâmina de água de irriga
ção e agitadas. O solo desprende-se das raízes e, então, será possível identificar as galhas.
Os técnicos do Instituto Rio-granden se do Arroz (Irga) e demais órgãos de pesquisa e universidades estão habilita dos a realizar a coleta de amostras para análise ou enviá-las a um laboratório para o diagnóstico.
Devido ao aumento da doença, na última safra foram realizados dois estu dos pelo Irga, no município de São Ga briel (RS), em lavouras com histórico de nematoides, para determinar o compor tamento das cultivares Irga 424 RI e Guri Inta-CL, ambas semeadas na densidade de 100kg/ha. Nessas lavouras foram es tabelecidos dois tratamentos: 1) áreas em que as plantas tinham sintomas de ataque do nematoide e 2) área sem sin tomas, com plantas normais.
Cada estudo constou de quatro repe tições, sendo avaliados em cada parcela a estatura de seis plantas ao acaso e o número de grãos por panícula em dez plantas ao acaso. A produtividade de grãos foi obtida pela colheita de 2m x 2m (4m2) da área útil de cada repetição, sendo os resultados expressos em t ha-1 e a umidade corrigida para 13%.
Na área atacada por Meloidogyne graminicola, na lavoura com a cultivar IRGA 424 RI, houve diminuição na es tatura de plantas e no número de grãos por panícula, o que causou uma redução na produtividade de grãos de 19% em
Tabela 1 - Produtividade e outras características agronômicas da cultivar de arroz irrigado
IRGA 424RI, com sintomas ou não de ataque de nematoides. São Gabriel, RS, 2021/2022
Tratamentos
IRGA 424 RI s/nematoides
IRGA 424 RI c/nematoides
Estatura (cm)
b
Grãos/Panícula
a 75 b
Produtividade de grãos (t ha-1) 9,72a 7,88 b
*Médias nas colunas seguidas da mesma letra não diferem entre si pelo teste de Duncan ao nível de 5% de significância.
Danos (%) 19
Tabela 2 - Produtividade e outras características agronômicas da cultivar de arroz irrigado

GURI INTA-CL, com sintomas ou não de ataque de nematoides. São Gabriel, RS, 2021/2022
Tratamentos
GURI INTA-CL s/nematoides
GURI INTA-CL c/nematoides
Estatura (cm)
a 67 b
Grãos/Panícula 84 a 75 b
Produtividade de grãos (t ha-1) 9,80 a 7,26 b
*Médias nas colunas seguidas da mesma letra não diferem entre si pelo teste de Duncan ao nível de 5% de significância.
comparação à área da mesma lavoura, sem o ataque do nematoide (Tabela 1).
Na área atacada por nematoide na la voura com a cultivar GURI INTA-CL, tam bém se verificou uma diminuição na es tatura de plantas e no número de grãos por panícula, reduzindo a produtividade de grãos em 26%, em relação a uma área da mesma lavoura sem a ocorrência da doença (Tabela 2). Nessas áreas das la vouras atacadas pelo nematoide foram observados os sintomas típicos, como presença de plantas amareladas e com formação de galhas nas raízes. Segundo Aita et al. (2019), a perda de coloração nas folhas pode ser ocasionada por uma menor absorção de nutrientes, resultan do em menores taxas fotossintéticas.

O arroz pode sofrer perdas na pro dutividade de grãos que chegam a 70% em áreas atacadas pelo nematoide M. graminicola (Kyndt et al., 2014).
Portanto, pelos danos causados e a disseminação do nematoide em todas as regiões orizícolas, atacando um maior número de lavouras, esse aumento da doença causa preocupação.
Danos (%) 26
Com o aumento das áreas atacadas por esse nematoide, é necessário adotar medidas para auxiliar na redução da po pulação, tais como:
• Antecipar a irrigação: a entrada da água na lavoura é muito importante. Com a antecipação da irrigação, a disse minação da doença será reduzida, um número menor de plantas será infecta do, ocorrendo redução na população do nematoide.
• Rotação de culturas: como a soja é atacada principalmente pela espécie M. javanica, diferentemente da cultura do arroz irrigado, onde ocorre, sobretu do, a espécie M. graminicola, a rotação entre essas culturas auxilia na redução da população do nematoide que ataca o arroz irrigado.
• Utilização de nematicidas: existem vários nematicidas com registro para o controle desse nematoide. Esses produ tos são aplicados através do tratamento de sementes. Os produtos biológicos Bacillus amyloliquefaciens e B. firmus apresentam um bom controle. A dose empregada é importante na eficiência. Produtos aplicados em pulverização após a irrigação apresentam baixo con trole, visto que o nematoide já colonizou as raízes.
C
Tailor P. Perufo Rudineli R. Carvalho e Matheus S. Corrêa, Instituto Rio-grandense do Arroz
Raiz de arroz com galhas Plantas de arroz atacadas por nematoide com menor estaturaCafé
Esses insetos podem auxiliar no manejo do bicho-mineiro do cafeeiro; tratam-se de predadores polífagos, encontrados em diversas culturas de interesse econômico
é uma
das pragas mais de vastadoras da cultura do café. Dependendo da safra, a desfolha pode chegar a 75% e as perdas na ordem de 90% da produtividade da cultura.
As fêmeas adultas desse inseto ovipositam na superfície adaxial das folhas, 60 ovos por fêmea du rante o ciclo de vida (Figura 1 A e D). Após a eclosão, as lagartas per furam a epiderme e se alimentam do mesófilo foliar formando minas (Figura 1C).
O dano restringe a superfície da folha, reduzindo a taxa fotos sintética e, consequentemente, a queda da folha, notavelmente intensificada quando as galerias são formadas próximo ao pecíolo foliar. Quando as lagartas abando nam as minas, tecem um fio de se da e se deslocam preferencialmen te para as folhas do terço inferior das plantas, que, por sua vez, se transformam em pupas no forma to de X (Figura 1 B).
No Brasil, os danos do bicho -mineiro podem prosseguir no ano seguinte, dependendo do nível de infestação, da duração, da idade do cafezal e da época de ocorrên cia. Assim, perdas consideráveis na produtividade podem existir se o produtor não manejar a lavoura corretamente.
As infestações causadas pelo bicho-mineiro dependem das con dições climáticas, como tempera tura, umidade relativa e precipita ção. A temperatura é o fator mais importante que afeta a biologia do inseto, como o tempo de desen volvimento e a reprodução. Essas infestações são mais frequentes

quando as condições de tempera turas são mais elevadas no período de seca (abril-outubro), que, neste caso, reduzem o ciclo de vida e au mentam o número de gerações des te inseto na lavoura. Dessa forma, a intensidade de ataque da praga pode ser mais intensa e severa no campo.
As populações de bicho-mineiro são menores durante o período chuvoso. Os ovos podem ser re movidos da superfície da folha e a composição química da planta me lhorada durante o período chuvoso. Neste período, as defesas químicas no tecido foliar podem afetar o pro cesso fisiológico no inseto, resul tando em mortalidade de lagartas. Além disso, o acasalamento entre macho e fêmea pode ser reduzido, pois esses insetos podem apresen tar dificuldade de voo durante as chuvas.
O controle de bicho-mineiro po de ser químico, genético, cultural ou biológico. Se forem aplicados no momento ideal, esses méto dos serão eficientes. Entretanto, o controle desse inseto é difícil de ser obtido em áreas não monitora das, onde muitas vezes o manejo é iniciado quando as populações de pragas se encontram altas. O mo mento ideal é quando o nível de in festação chega a 3% das folhas mi nadas com a presença de lagartas vivas. Por isso, os produtores de vem ficar atentos à época de maior infestação e realizar o controle no momento correto.
A escolha de uma variedade re sistente ao bicho-mineiro, como, por exemplo, a Siriema, pode ser uma opção para reduzir essa população. O método cultural consiste em criar um ambiente favorável ao desenvol vimento da planta e prejudicial ao inseto. Por outro lado, quando ocor re um desequilíbrio entre nitrogênio e potássio, na maioria dos casos, acentua-se a infestação de bicho-mi neiro. Isto ocorre quando os teores de N estão muito elevados em com paração com os teores de K, desta forma as folhas tornam-se mais sus
cetíveis por conta do intenso cres cimento vegetativo. Além disso, as plantas de café com espaçamento bem arejado favorecem a infestação da praga. Assim, vale ressaltar que o uso de quebra-ventos, a adubação equilibrada e o adensamento de plantas podem ser importantes para o manejo.
O controle químico pode ser re alizado com aplicação de inseticidas granulados no solo ou pulverizações aéreas. Este método é o mais utili zado, pois a sua ação é rápida e na maioria das vezes mais eficiente. O controle preventivo do bicho -mineiro deve ser realizado no pe ríodo que antecede a estação seca do ano, e na área que tem histórico de incidência. Os meses de março e abril seriam ideais para iniciar esse controle. Os inseticidas dos grupos químicos organofosforado, neonico tinoide, espinosinas, diamida, car bamato, piretroide e os fisiológicos são registrados para o controle de bicho-mineiro. No entanto, alguns desses inseticidas são persistentes no ambiente e pouco seletivos aos inimigos naturais. Além disso, o au
mento do número de aplicação de inseticida tem gerado populações resistentes, além dos impactos am bientais negativos. Assim, torna-se importante integrar ao método quí mico o controle biológico, uma vez que pode ser muito efetivo desde que utilizado corretamente.
O controle biológico consiste em usar predadores, parasitoides, fun gos e bactérias para controlar o in seto-praga. Dentre os diversos inimi gos naturais existentes no ambiente destacam-se os crisopídeos, insetos predadores, durante a fase larval. O crisopídeo é um predador polífago que pode ser encontrado em diver sas culturas de interesse econômico, milho, sorgo, algodão, cana-de -açúcar, citros, fumo, videira e café. As larvas desse inseto se alimentam de pulgões, ácaros, mosca-branca, cochonilha, tripes, psilídeos, ovos e lagartas de Lepidoptera, por isso vêm sendo utilizadas no controle biológico para reduzir a população de bicho-mineiro no café (Figura 2).
O crisopídeo apresenta o de senvolvimento holometábolo, isto é, dos ovos eclodem as larvas, que

passam de pupa à fase adulta. Os ovos desse inseto são reconhecidos por possuírem um pedicelo hialino e alongado, sendo encontrados de forma isolada ou agrupada (Figura 2A). O pedicelo é a principal defesa de ovos contra predadores, como a formiga. As larvas têm formato alon gado, com pontas mais estreitas, e podem atingir até 8mm. São ágeis e suas mandíbulas são arqueadas e robustas, com dimensões superio res à da própria cabeça (Figura 2B). Além disso, as larvas podem ou não carregar na parte dorsal do corpo os restos das suas presas, exúvias, pedaços de folhas e gravetos como estratégia de camuflagem e defesa contra seus inimigos naturais (Figu ra 2C). Na fase adulta, esses insetos são facilmente reconhecidos por possuírem coloração esverdeada, olhos compostos de cor dourada e asas membranosas, transparentes e

com muitas nervuras (Figura 2D).
O crisopídeo pode ser usado no controle biológico aplicado ou na tural. O primeiro método consiste em liberar o predador no campo a partir de criações artificiais em la boratório, com impacto direto sobre a população de bicho-mineiro. O segundo método de controle bioló gico consiste na preservação desse inseto que ocorre naturalmente no campo. O controle biológico aplica do é bastante promissor devido à facilidade de criação de crisopídeo em laboratório e às larvas com alta capacidade predatória.
A criação e a comercialização de crisopídeo são realizadas em Minas Gerais, através da empresa Amipa (Associação Mineira de Produtores de Algodão). Após a criação, o criso pídeo pode ser liberado na fase de ovo, larva, pupa ou adulta, sendo o mais comum a liberação de ovos no
campo. Antes da liberação, os ovos são misturados juntamente com o farelo de trigo e, posteriormente, aplicados sobre as plantas de café. Atualmente, é liberada a dose de mil ovos de crisopídeos por hectare a cada 30 dias com uso de drones mo nitorados por GPS. Essas liberações são realizadas quando o nível de in festação atinge o nível de controle, e devem ser feitas em áreas adequa das para multiplicação de insetos.
Após a liberação dos ovos de cri sopídeos, o produtor deverá realizar um bom manejo para maximizar a eficiência de predação. Os adultos apresentam alta mobilidade e capa cidade de voo. Esses insetos, na fase adulta, procuram alimentos, como néctar e pólen de plantas. Por isso, o manejo adequado consiste em man ter diversidade de plantas por meio de consórcio de culturas, faixa de plantas florestais, cercas vivas e adu bos verdes, como a crotalária e trigo mourisco. Essas plantas aumentam a sobrevivência e a permanência do crisopídeo no campo, pois fornecem alimentos com alto teor de proteí nas e açúcares.
A utilização de inseticidas no campo deve ser realizada quando esses apresentarem seletividade ao crisopídeo. Alguns inseticidas, como cartape, piriproxifem, fenpropatrina e zeta-cipermetrina, não apresenta ram toxicidade a ovos, larvas, pupas e adultos de crisopídeo. Neste caso, esses inseticidas podem ser usados juntamente com o controle biológi co de bicho-mineiro.
Assim, o crisopídeo, associado a outras práticas de controle, pode ser uma ferramenta para manter as populações do bicho-mineiro abaixo no nível de dano econômico.
Flávio Lemes Fernandes Mariana Martins Fernandes Oliveira Dayse Menezes Dayrell e Maria Elisa de Sena Fernandes, Universidade Federal de Viçosa Carlos Gustavo da Cruz e Walyson Silva Soares, Universidade Federal de Uberlândia

Acompanhamento da incidência de doenças em soja nas três últimas safras no Mato Grosso do Sul aponta a necessidade de atenção para as particularidades de cada momento
Caracterizada como uma das principais commodities do Brasil, a soja possui importância econômica mundial. No Mato Grosso do Sul, a safra de 2020/21 superou as expec tativas de produção e foi 17,8% maior que a de 2019/2020. Essa safra (2020/21), inicialmente, teve um clima distinto, com pou cas possibilidades de plantio em Outubro, seguido de um veranico no início de outubro. Isto fez com que os produtores interrompessem o plantio, retomando as atividades em meados de outubro e até início de novembro, especialmente nas regiões Norte e Sul (linha da BR163, que corta o estado do Mato Grosso ao Paraná), para a região dos Chapadões (Leste do estado), onde as interferências climáticas foram marcantes, porém com pouca variação das condições usuais daquela região.
O Mato Grosso do Sul, nas três últimas safras, demonstrou cenário diferente quanto à ocorrência de doenças na cultura da soja, em es pecial para ferrugem-asiática (Phakopsora pachyrhizi) e mancha-alvo (Corynespora cassiicola).

Na safra recém-finalizada, a ferrugem apresentou ocorrência tardia e índice de severidade muito baixo. Quando com parado a anos anteriores, talvez o mais baixo desde a safra 2001/02 (Figura 1). Por outro lado, houve um crescimento na ocorrência de mancha-alvo (Figura 2), certamente relacionado à janela de plantio antecipada, bem como a altera ções climáticas (instabilidade de chuvas em outubro, temperaturas altas em no vembro e dezembro, janeiro intercalan do com excesso de chuva e dias nubla dos), ciclo das cultivares (em torno de 100 a 118 dias), assim como novas cul tivares (maior teto produtivo) inseridas no planejamento do produtor. Nessas condições estão cerca de 70% a 80% das áreas cultivadas, independentemente da região do estado de Mato Grosso do Sul.

A Desafios Agro, com bases de pes quisa em Chapadão do Sul, Bandeiran tes, Campo Grande, Sidrolândia e Dou rados, registrou ocorrência das seguintes doenças na cultura da soja:
• Dourados e Sidrolândia, inicial mente na fase vegetativa (entre V3 a V8), demonstraram leve ocorrência de septoria (Septoria glycines), antracnose (Colletotrichum truncatum) e mancha -alvo, seguindo o reprodutivo da cultura, R5.3/5.4 (plena formação dos grãos), até o final do ciclo, com severidade oscilan do em função do grau de sensibilidade das cultivares. A ferrugem e a cercospora (Cercospora kikuchii) foram constatadas no final do ciclo, a partir de R6, com focos isolados e baixos índices de severidade.

• Para a região central (Bandeiran tes), inicialmente houve leve ocorrência de septoria na fase vegetativa (V4 a V6), posteriormente surgiu a mancha-alvo, a partir de R5.1, que seguiu até o final do ciclo da cultura, porém, com índices mo derados, tornando-se, assim, a principal doença de ocorrência na região central do estado. Por outro lado, a ferrugem e a cercospora apareceram em focos isolados e baixos índices de severidade.
• Para a região dos Chapadões, ini cialmente observou-se baixa incidência de septoria na fase vegetativa, entre V4 e V6 (completamente diferente da safra anterior, que se estendeu até o final do ciclo da soja). Posteriormente, a partir de R5.1 (início enchimento de grãos),
surgiu a mancha-alvo, que seguiu até o final do ciclo da soja, com índices severo e intenso, classificando-se como principal doença de ocorrência na região.
Dentre as estratégias de controle de doenças, o químico ainda se destaca co mo alternativa mais utilizada. Os produ tores rurais, através de seus técnicos e consultores, sempre optam por efetuar um programa completo de fungicidas específicos (estrobilurinas, carboxami das e triazóis) que contemplam efetivi dade para o manejo da ferrugem e da mancha-alvo. Assim, para as cultivares de ciclo curto realizam-se em média três aplicações, ainda que alguns poucos fa zem apenas duas. Para as cultivares de ciclo mais longo seguem as mesmas três aplicações e alguns poucos realizam qua tro pulverizações.
Um dos objetivos de trabalho da Desa fios Agro é buscar informações que con templem as mesmas condições enfren tadas pelo produtor. Nessa perspectiva foi conduzido um ensaio comparativo de fungicidas, em diversas regiões de Mato Grosso do Sul, onde foram utilizadas va riedades e épocas de semeadura de soja condizentes às praticadas em cada região produtora do estado (Tabela 1).
Os resultados de produtividade mos tram a variabilidade dos principais fungi cidas nos diferentes ambientes de pro dução em todo o estado. Desta maneira, reforçam-se ainda mais a necessidade e a preocupação de uso destas ferramentas, visto a necessidade de entendimento re gional (patógeno-ambiente-hospedeiro) para que seja tomada a melhor decisão, tanto do produtor quanto do técnico res

Em áreas de soja com semeadura cedo, doenças como a mancha-alvo têm predominado; produtores acostumados a pensar na ferrugem não devem ignorar as outras ameaças
Aincidência de doenças na cultura da soja tem muda do nos últimos anos com o aumento da utilização de cultivares precoces, semeadas após o final do perí odo de vazio sanitário, para permitir uma segunda safra de milho na maioria das vezes.
Embora a ferrugem-asiática sempre seja lembrada pelos pro dutores como a principal doença da cultura, em razão dos danos que causa, sua incidência tem sido cada vez mais tarde nas regiões e lavouras, sendo um problema principalmente no final do ciclo ou nas semeaduras e nas regiões que semeiam mais tarde pelo aumento do inóculo do fungo. Nas áreas semeadas mais cedo, outras doenças têm predominado, entre elas a mancha-alvo, causada pelo fungo Corynespora cassiicola.
Os sintomas da mancha-alvo podem aparecer desde o pe ríodo vegetativo. Nas folhas, se iniciam por pontuações pardas, evoluindo para manchas circulares, de coloração castanho-claro a castanho-escuro com halo amarelado. Normalmente, as man
chas apresentam uma pontuação no centro e anéis concêntri cos de coloração mais escura, advindo daí o nome da doença. Dependendo da reação da cultivar, as lesões podem atingir até 2cm de diâmetro ou permanecer pequenas (1mm a 3mm), mas em maior número. Também podem ocorrer manchas em pecí olos, hastes, nervuras das folhas e vagens, sendo muitas vezes confundida com antracnose.
Além da soja, o fungo C. cassiicola infecta mais de 530 espécies de plantas e 380 gêneros, incluindo mono e dicotiledôneas, sendo algumas importantes culturas utilizadas na rotação ou sucessão no Mato Grosso, Mato Grosso do Sul, Goiás e Bahia, como algo dão e crotalária, além de diversas plantas daninhas. Apesar de testes de inoculações cruzadas mostrarem que isolados do fungo são mais agressivos quando inoculados no hospedeiro de origem, indicando evidências de especialização, isolados obtidos de soja e algodão no Brasil infectam ambas as culturas. O fungo pode colonizar uma ampla gama de resíduos no solo e sobreviver em
 C. Meyer
C. Meyer
restos de cultura e sementes infectadas.
Condições de alta umidade relativa, com precipitações bem distribuídas, são favoráveis à infecção e ao desenvol vimento da doença. Em ambientes de alta umidade e temperaturas de 20°C a 30°C, os sintomas aparecem de cinco a sete dias após a infecção. Uma vez den tro da planta hospedeira, o patógeno pode liberar a cassiicolina, uma toxina que mata os tecidos adjacentes ao local da infecção.
Algumas cultivares apresentam boa tolerância à desfolha e a presença da doença só é notada nas folhas inferiores. Conhecer a reação da cultivar à mancha -alvo é o primeiro passo na definição de um programa de manejo com fungicidas. Perdas de até 40% podem ser observa das em cultivares suscetíveis.

O fungo C. cassiicola possui alta varia bilidade e a resistência a fungicidas tem sido um problema crescente. Baixa efici ência tem sido observada para fungicidas do grupo metil benzimidazol carbamato (carbendazim) nos ensaios em rede des de 2011/2012. Fungicidas inibidores de quinona externa (IQe - estrobilurinas) também têm baixa eficiência para con trole de C. cassiicola
A resistência do fungo C. cassiicola às estrobilurinas vem sendo relatada desde 2015/2016 no Brasil em número significativo de amostras, em razão da presença da mutação G143A que con fere resistência completa. Isolados com
sensibilidade reduzida para os fungicidas inibidores da succinato desidrogenase (IS DH, carboxamidas) foram encontrados a partir de 2016/2017. A maioria das po pulações analisadas no Brasil é portado ra da mutação C-N75S, sendo B-H278Y a segunda mutação mais frequente. A fre quência de isolados com mutações sdh tem sido maior nos isolados coletados em Mato Grosso e no Mato Grosso do Sul em comparação a outras regiões (https:// www.frac.info/knowledge-database/ summary-of-annual-monitoring).
Desde a safra 2011/2012, experi mentos em rede vêm sendo realizados, em diferentes regiões produtoras, para a comparação da eficiência de fungicidas registrados e em fase de registro para o controle da mancha-alvo na cultura da soja. O objetivo dos experimentos em re de é a avaliação da eficiência de controle no alvo biológico. Para isso, são utilizadas aplicações sequenciais de fungicidas. No entanto, isso não constitui uma recomen dação de controle. As informações devem ser utilizadas dentro de um sistema de manejo, considerando a suscetibilidade da cultivar, a incidência de outras doenças e priorizando sempre a rotação de fungi cidas com diferentes modos de ação para atrasar o aparecimento de resistência dos fungos aos fungicidas.
Na safra 2021/2022, foram realiza dos 21 experimentos por 18 instituições de pesquisa, em estações experimentais no Mato Grosso do Sul, no Paraná, em
Mato Grosso, em Goiás, em Tocantins e na Bahia. A doença tem sido mais seve ra nas regiões do Cerrado, em razão do maior volume e da melhor distribuição das chuvas. Os experimentos do Paraná não tiveram ocorrência da doença, em razão da má distribuição das chuvas na safra. Nas análises, os experimentos com incidência de outras doenças tiveram a variável produtividade eliminada.

Foram avaliados 13 fungicidas e um programa que incluiu a rotação de fun gicidas (Tabela 1). Os fungicidas dos tra tamentos 4, 6, 9, 13 e 14 ainda estão em fase de registro. As aplicações iniciaram -se no pré-fechamento das linhas de se meadura (49 dias ± cinco dias), repetidas com intervalos de 14 dias, totalizando três a quatro aplicações.
Em todos os experimentos foram utilizadas cultivares consideradas susce tíveis à mancha-alvo, com base em ob servações a campo. As áreas para insta lação dos experimentos foram semeadas no início da época recomendada, para reduzir a probabilidade de incidência da ferrugem-asiática.
Todos os tratamentos apresentaram severidade inferior à testemunha sem fungicida. As menores severidades e as maiores porcentagens de controle foram observadas nos tratamentos com dife noconazol + protioconazol + mancozebe (T13 – 73%), azoxistrobina + protiocona zol + mancozebe (T12 – 72%), picoxis trobina + protioconazol + mancozebe
Tabela 1 - Severidade da mancha-alvo (SEV), porcentagem de controle em relação à testemunha sem fungicida (%C), produtividade (PROD) e porcentagem de redução de produtividade (%RP) em relação ao tratamento com a maior produtividade, para os diferentes tratamentos. Média de 16 experimentos para severidade e 12 experimentos para produtividade. Safra 2021/2022
Tratamentos: ingrediente ativo (i.a.)
1. Testemunha
2. piraclostrobina + fluxapiroxade1
3. bixafen + protioconazol + trifloxistrobina2
4. piraclostrobina + difenoconazol + protioconazol3,10
5. protioconazol + fluxapiroxade4
6. protioconazol + fluindapir5,10
metominostrobina + tebuconazol6
protioconazol + mancozebe7
clorotalonil + fluindapir8,10
tebuconazol + clorotalonil9,11
protioconazol + fluxapiroxade + mancozebe7,11
azoxistrobina + protioconazol + mancozebe5
difenoconazol + protioconazol + mancozebe2,10
picoxistrobina + protioconazol + mancozebe2,10
Programa12
116,55 + 58,45
+ 87,5 + 75 90 + 60 + 90 80 + 64 84 + 84 79,75 + 119,63 90 + 1.125 1.000,08 + 79,92 125 + 1.125 70,875 + 50,625 + 990 75 + 75 + 1.050 75 + 87 + 1.263 99 + 87 + 1.239
SEV (%)
A 26,9 B 18,1 E 15,4 G 16,6 FG 17,9 EF 22,3 C 13,8 H 20,1 D 17,6 EF 13,6 HI 12,5 IJ 11,8 J 12,8 HIJ 14,0 H
PROD
associação com multissítios e rotação de modos de ação, pode atrasar a seleção de populações resistentes, prolongando a vi da útil dos fungicidas. Todas as estratégias devem ser incluídas no manejo da doença, como a utilização de cultivares resistentes/ tolerantes, o tratamento de sementes e a rotação/sucessão de culturas com milho e/ ou outras espécies de gramíneas.
Resultados de safras anteriores podem ser consultados nas circulares técnicas dis poníveis em: https://www.embrapa.br/soja/ publicacoes.
Cláudia V. Godoy
Médias seguidas de mesma letra na coluna não diferem entre si pelo teste de Tukey (p≤0,05). 1Adicionado Assist 0,5 L/ha; 2Adicionado Aureo 0,25% v/v; 3Adicionado Agefix E8 0,3 L/ha; 4Adicionado Mees 0,25
v/v; 5Adicionado
0,25% v/v;
Iharol Gold 0,25% v/v; 7Adicionado Rumba 0,25 L/ha; 8Adicionado X3P15 200 mL/ha; 9Adicionado
mL/ha;
(T14 – 71%), seguido de protioconazol + fluxapiroxade + mancozebe (T11 – 69%), protioconazol + mancozebe (T8 – 69%) e do programa com rotação de fungicidas (T15 – 68%) (Tabela 1). Todos os fungici das com eficiência ≥ 69% possuem pro tioconazol e mancozebe na formulação, semelhante à safra 2020/2021, em que fungicidas com protioconazol e manco zebe ficaram no grupo com maior efici ência de controle.
A menor porcentagem de controle foi observada para o tratamento pira clostrobina + fluxapiroxade (T2 – 39%), variando de 20% a 65% nos experimen tos. Esse tratamento foi incluído para monitoramento da carboxamida. No en tanto, não foi possível avaliar a eficiência na região Sul, onde há menor frequência de isolados do fungo com mutações, pela ausência da doença nos experimentos.
Sintomas de fitotoxicidade do tipo necrose internerval de folhas superiores (folha carijó) foram observados em cinco experimentos, nos tratamentos com te buconazol e protioconazol, em diferen tes severidades e em menor intensidade ou ausente na presença de mancozebe em mistura.
As maiores produtividades foram observadas para os tratamentos com azoxistrobina + protioconazol + manco zebe (T12 – 4.312kg/ha), protioconazol + mancozebe (T8 – 4.312kg/ha), para o programa com rotação de fungicidas
(RET)
11Produto sem registro para o alvo biológico. 12PROGRAMA: (1) Fox Xpro 0,5 L/ha + Áureo 0,25% v/v/ (2) Armero 2,25 L/ha + Rumba 0,25 L/ha/ (3) Blavity 0,3 L/ha + Mees 0,25 % v/v + Manfil WP 1,5 kg/ha (mancozebe)/ (4) Orkestra 0,35 L/ha + Assist 0,5 L/ha + Previnil 1,5 L/ha (clorotalonil)
(T15 – 4.297kg/ha), difenoconazol + pro tioconazol + mancozebe (T13 – 4.273kg/ ha), picoxistrobina + protioconazol + mancozebe (T14 – 4.227kg/ha), protio conazol + fluxapiroxade + mancozebe (T11 – 4.208kg/ha), piraclostrobina + difenoconazole + protioconazol (T4 –4.150kg/ha), bixafen + protioconazol + trifloxistrobina (T3 – 4.138kg/ha) e pro tioconazol + fluxapiroxade (T5 – 4.136kg/ ha) (Tabela 1). A média da redução de produtividade da testemunha sem fun gicida em relação à maior produtivida de (T8 e T12 – 4.312kg/ha) foi de 18,6% (803kg/ha).
Nos ensaios em rede para avaliação de fungicidas para controle da mancha -alvo são utilizadas cultivares mais sus cetíveis à doença. Conhecer a reação da cultivar à doença é o primeiro passo na definição de um programa de manejo com fungicidas. Muitas cultivares apre sentam boa tolerância/resistência a essa doença e não necessitam de controle, e para aquelas que precisam, é necessá rio a escolha dos fungicidas adequados, uma vez que nem todos apresentam boa eficiência.
Monitoramentos regionais são ca da vez mais importantes para conhe cer a sensibilidade dos patógenos aos fungicidas. A adoção de estratégias an tirresistência, como limitar o número de aplicações de carboxamidas a duas aplicações por ciclo da cultura da soja,
Maurício C. Meyer e Ivani de Oliveira N. Lopes, Embrapa Soja Carlos M. Utiamada, Tagro Tecnologia Agropecuária Ltda Hercules D. Campos, Universidade de Rio Verde Alana Tomen e Ivan Pedro A. Júnior, Proteplan Pesquisa e Assessoria Agrícola Ana Cláudia R. Mochko, Fundação MS Alexsandro de Farias, ALX Farias Agro Pesquisa Ariel Muhl e
João Mauricio T. Roy, Centro de Pesquisa Agrícola Copacol Diego Sichocki e Luís Antônio de Sousa Lima, Meta Consultoria Agrícola Eder N. Moreira, Fitolab Pesquisa e Desenvolvimento Agrícola Fabíola T. Konageski e Tiago F. Konageski, Rural Técnica Experimentos João Carlos Bonani e Marcos V. Garbiate, Coamo
José Nunes Junior, Centro Tecnológico para Pesquisas Agropecuárias Karla Kudlawiec e Mônica A. Müller, Fundação Mato Grosso Luana M. de Rossi Belufi, Fundação de Pesquisa e Desenv. Tecnológico Lucas Henrique Fantin, Fundação Chapadão Luís Henrique Carregal, Agro Carregal Pesquisa e Proteção de Plantas Marcio Goussain Júnior, Assist Consultoria e Experimentação Agronômica Mônica C. Martins, Círculo Verde Assessoria Agronômica e Pesquisa Nédio R. Tormen, Instituto Phytus


Sistemas de cultivo comumente praticados têm permitido a maior incidência desses animais; boas sementes, manejo de plantas não cultivadas, de solo e outras medidas auxiliam o produtor
Ossistemas de cultivo comu mente praticados no Brasil têm possibilitado o aumen to populacional de várias espécies de nematoides. A soja é líder nacional do ranking das major crops e é também uma das espécies vegetais que hospe dam maior diversidade de nematoides de importância agrícola. Dentre os prin cipais nematoides das culturas de soja, milho e algodão, destacam-se as espé cies Heterodera glycines, que infecta so mente a soja, Rotylenchulus reniformis, parasita soja e algodão, Meloidogyne javanica, patogênico à soja e ao milho, e M. incognita e Pratylenchus brachyurus,
que parasitam as três culturas.
Além dessas espécies, algumas ou tras têm chamado a atenção pelo au mento na frequência em que aparecem nas análises e os altos níveis populacio nais. Aqui, destacam-se Aphelenchoides besseyi, que parasita soja e algodão, e Helicotylenchus dihystera e Scutellone ma brachyurus, cuja gama de hospedei ros ainda precisa ser elucidada. Dentro dos fatores que agravam os problemas nematológicos nos sistemas de cultivo, citam-se as populações mistas, predo minantes em todas as regiões agrícolas do País.
Frente a esse cenário, o manejo de nematoides é um grande desafio, pois todas as estratégias apresentam limita ções quando adotadas isoladamente, e ele está sustentado por quatro pilares principais, sendo eles os controles gené tico, químico, biológico e cultural.
O controle genético caracteriza-se pela adoção de cultivares resistentes ou moderadamente resistentes. E o uso dessa tecnologia é lastreado na medida em que aumentam os tamanhos das áreas, aumentam, também, as produti vidades obtidas, inferindo-se que, prova
velmente, esse fato seja decorrente de maiores níveis de tecnologias aplicadas e de melhor gestão das propriedades rurais. Contudo, em contrapartida, os problemas de ordem fitossanitária são, também, crescentes.
O controle genético pode ser enten dido como método ideal de manejo por que é eficiente na redução populacional do nematoide e não aumenta o custo de produção, uma vez que a ferramenta de manejo é a resistência genética embar cada na própria semente. Essa via de controle soma o desenvolvimento de cultivares com bom desempenho agro nômico e obtenção de ganhos genéticos com a eliminação de outros fatores res tritivos à produtividade com a incorpo ração de resistência a doenças fúngicas e bacterianas.
No mercado nacional, quando con sideramos as culturas de soja, milho e algodão, poucas opções estão disponí veis no mercado com níveis elevados de resistência quando consideramos os nematoides de galhas, Meloidogyne spp. e o nematoide de cisto da soja, H. glycines. Para P. brachyurus, entretanto, até o momento não foram encontradas fontes de resistência.
Dentro do controle químico, citam -se como principais ativos do mercado carbamatos e organofosforados (tiodi carbe, cadusafós, fenamifós e terbufós), abamectina, fluensulfona, fluazinam + tiofanato metílico e fluopyram. Tais produtos têm sido recomendados para o uso em tratamento de sementes (TS) ou sulco de semeadura. Os resultados das pesquisas apontam reduções médias de 20% a 80% na população de nema toides, principalmente na fase inicial de desenvolvimento. Ganhos de produtivi dade também são observados, variando de acordo com a população presente e demais técnicas de controle adotadas.
Os mecanismos de ação dos nema ticidas nem sempre são facilmente de tectados por envolver diferentes sítios de atuação no nematoide ou ter efeitos combinados. Os organofosforados e os carbamatos atuam como nematicidas inibindo a enzima acetilcolinesterase, causando a cessão de impulsos nervo
sos, levando à morte do nematoide. A abamectina também tem ação sobre essa mesma enzima e efeito deletério sobre a atividade de ATPase, atuando como uma neurotoxina, provocando insuficiência respiratória no nematoide (Nars, 2015).
No entanto, apesar desses efeitos, o mecanismo de ação atribuído à aba mectina é o bloqueio da transmissão do impulso elétrico entre a célula nervosa e o músculo, pela abertura ininterrupta dos canais de cloreto nas membranas celulares. Esse nematicida inibe a eclo são de ovos e causa paralisia em juve nis, irreversíveis em alguns gêneros. Os isocianatos atuam de diversas maneiras nas células, sendo a inibição da cadeia transportadora de elétrons, a inativação enzimática e a sinalização para apoptose celular as principais formas.
Os princípios ativos fluensulfona e fluopyram integraram a lista de nemati cidas químicos registrados recentemente para as major crops, com mecanismos de ação distintos das demais moléculas presentes no mercado. A fluensulfona tem ações pleiotrópicas e inibe o desen volvimento, a postura e a incubação de ovos, alimentação e locomoção. O perfil desses efeitos é notavelmente distinto de outras classes de anti-helmínticos e nematicidas: a inibição da motilidade causada pela fluensulfona não é acom panhada pela hipercontração caracterís tica de organofosforados e carbamatos (Kearn et al., 2014). A fluopyram atua como um inibidor da enzima succinato desidrogenase, no processo respiratório do nematoide (Beeman & Tylka, 2018), cessando a produção de ATP e levando

o nematoide à morte. Cabe salientar que a persistência da fluopyram no so lo é superior à dos demais nematicidas descritos anteriormente.
O controle biológico é apontado co mo o método de manejo de nematoi de que mais cresceu nos últimos anos. Atualmente, o Ministério da Agricultura, Pecuária e Abastecimento (Mapa) conta com, aproximadamente, 50 nematicidas biológicos registrados para o controle de nematoides, os quais podem ser adota dos para tratamento de sementes ou aplicação em sulco de semeadura. Os produtos biológicos podem ser à base de fungos ou bactérias.
Os bionematicidas fúngicos são formulados a partir de Pochonia chla mydosporia, Purpureocillium lilacinum (= Paecilomyces lilacinus), Trichoderma harzianum e T. koningiopsis. Todas es sas espécies são saprófitas, o que indi ca a capacidade de sobreviver no solo na matéria orgânica em decomposição.
Dentro do controle biológico, as bac térias representam a maior parte dos bionematicidas registrados no Brasil. Aqui, citam-se as bactérias do gênero Pasteuria, que possuem alta especifici dade de hospedeiro e não sobrevivem de forma saprofítica no solo. Por outro lado, formam esporos de resistência de nominados endósporos, resistentes a inúmeras condições adversas. O gênero conta com várias espécies, no entanto, somente a P. nishizawae possui registro no País, sendo indicada exclusivamente para o controle de H. glycines.
Diferentemente dessa espécie, as bactérias do gênero Bacillus caracteri zam-se por apresentar ampla gama de
O controle genético pode ser entendido como método ideal de manejo porque é eficiente na redução populacional do nematoide e não aumenta o custo de produçãohospedeiros, com cepas para o controle dos principais nematoides que infectam a soja. Cepas de seis espécies de Bacillus já foram registradas no Brasil como bio nematicidas, sendo elas B. amyloliquefa ciens, B. firmus, B. liqueniformis, B. me thylotrophicus, B. subtilis e B. velezensis, sendo possível encontrar no mercado nacional produtos de cepas únicas ou mistas. O número elevado de produtos à base de Bacillus deve-se a uma série de fatores, incluindo facilidade de produção, armazenamento e aplicação.
Um aspecto importante a ser consi derado quando se trata do biocontrole é que a atividade biológica de todos os agentes mencionados sobre o nematoi de é totalmente dependente da cepa utilizada. Assim, apesar de centenas de cepas serem avaliadas anualmente, ape nas uma parte delas alcança o status de produto comercial.
Nesse cenário dos métodos mais importantes para o manejo de nema toides, destaca-se também a rotação de culturas. Diferentes plantas podem compor o sistema de rotação, incluindo espécies antagonistas, não hospedeiras e hospedeiras desfavoráveis, também chamadas de más hospedeiras. Entende -se por plantas antagonistas aquelas que produzem alguma substância ou têm algum método de ação direto sobre o nematoide. Um dos principais exemplos é a Crotalaria spectabilis, que, juntamen te com a C. breviflora, compõe o grupo de plantas antagonistas aos principais nematoides da cultura da soja, sendo, desta forma, as mais recomendadas visando reduzir nematoides em popu lações mistas. Ainda dentro do grupo das crotalárias, tem-se as espécies C. ochroleuca e C. juncea, no entanto, a primeira é suscetível a algumas raças de
H. glycines e a segunda a P. brachyurus, sendo necessário identificar as espécies de nematoides presentes na área.
As plantas não hospedeiras com preendem um grupo de espécies que o nematoide não tem preferência para se alimentar. Um bom exemplo é a reação das espécies de braquiária frente aos nematoides Meloidogyne spp. e H. gly cines. Neste caso, a planta exerce baixa atração sobre os nematoides, os quais geralmente não penetram suas raízes, ou penetram em número muito reduzido, e quando isso ocorre, não conseguem se desenvolver. Por fim, há o grupo das plantas más hospedeiras, caracterizadas por apresentarem fator de reprodução próximo a um para determinados ne matoides. Essas plantas não são consi deradas redutoras de nematoides, mas também não permitem o aumento po pulacional expressivo do patógeno. Aqui, tem-se como exemplos o nabo forragei ro e a aveia-preta frente a P. brachyurus, e a aveia-branca para Meloidogyne spp.

Dentro do conceito de rotação de culturas, é importante lembrar que, di ficilmente, o produtor optará por retirar a soja do sistema de produção anual. Por isso, geralmente recomenda-se a rota ção da cultura de sucessão, ou seja, a substituição do milho. Outro grande de safio da rotação de culturas é o manejo de populações mistas, visto que a planta pode ser redutora de uma espécie de ne matoide, mas suscetível a outra. Assim, conhecer as espécies presentes na área e realizar o planejamento assistido por um nematologista é algo primordial para reduzir as chances de erro.
Mais uma vez, deve-se lembrar da importância do manejo integrado de ne matoides. Desta forma, mesmo quando o produtor opta pelo uso de cultivares
resistentes ou com baixo FR, recomenda -se a proteção das mesmas com nema ticidas químicos ou biológicos, devido à possibilidade de ocorrência de raças ou populações agressivas dos nematoides. Ainda dentro do manejo integrado, a rotação de culturas deve ser associada ao controle biológico ou químico, uma vez que a primeira tem como objetivo reduzir as populações do nematoide e/ ou melhorar as características do solo, enquanto a segunda objetiva proteger a planta do ataque desses patógenos.
O manejo de nematoides é um dos grandes desafios no processo de rom pimento dos patamares produtivos das major crops. Mas vale sempre ressaltar que a execução correta desse manejo de ve ser associada a outras práticas, como escolha de sementes de boa qualidade e adaptadas à região de cultivo, manejo correto de doenças, plantas voluntárias e plantas daninhas, adubação orgânica, manejo do solo, entre outras. C
 Fernando Godinho de Araújo, IF Goiano Claudia Regina Dias Arieira, UEM
Tatiane Cheila Zambiasi, Agromax Adriana Figueiredo, Bayer
Conhecer as espécies presentes na área e realizar o planejamento assistido por um nematologista é algo primordial para reduzir as chances de erro
Bactérias do gênero Bacillus caracterizam-se por apresentar ampla gama de hospedeiro, com cepas para o controle dos principais nematoides que infectam a soja
Fernando Godinho de Araújo, IF Goiano Claudia Regina Dias Arieira, UEM
Tatiane Cheila Zambiasi, Agromax Adriana Figueiredo, Bayer
Conhecer as espécies presentes na área e realizar o planejamento assistido por um nematologista é algo primordial para reduzir as chances de erro
Bactérias do gênero Bacillus caracterizam-se por apresentar ampla gama de hospedeiro, com cepas para o controle dos principais nematoides que infectam a soja

Apodrecimento é novo desafio que surgiu nas últimas safras para o produtor de soja; pode haver ligação com a presença de mais de um tipo de fungo
Aanomalia ou o apodrecimento de vagens da soja vem ocorrendo em áreas de produção em alguns estados brasileiros nas últimas três safras. Porém, na safra 2021/22 houve alta intensidade no Estado do Mato Grosso, principal mente nos municípios de Sorriso, Sinop, Lucas do Rio Verde, Ipiranga do Norte e Tapurah. De acordo com o comunicado técnico emitido pela Embrapa Soja (2022), o problema ocorreu a partir do estádio de desenvolvi mento R5.4 (51% a 75% da formação de grãos), causan do redução de 20% na produtividade da soja e de 30% na qualidade de grãos.
Os sintomas desse problema são observados nas par tes mediana e baixeira das plantas, e aparecem como apodrecimento na junção das vagens que evoluem para necrose parcial ou total desse órgão, causando podri dão, abertura e, algumas vezes, abortamento das vagens (Figura 1A, 1B e 1C). As sementes oriundas das vagens atacadas também ficam comprometidas, e observa-se aspecto enrugado com alteração de cor (escurecido ou pálido) devido ao ataque de patógenos, sempre com as pecto seco, e não úmido, que é característico do ataque de bactérias (Figura 2A, 2B, 2C e 2D).

Vários pesquisadores de instituições públicas e pri vadas visitaram o Mato Grosso visando determinar as causas desse problema.
O primeiro passo foi correlacionar as condições edafoclimáticas, como estresse hídrico e térmico, em período anterior ao evento. Além disso, verificou-se a ocorrência de anomalia em diferentes cultivares, suge rindo que há variação na resposta dos materiais, mas ne nhuma cultivar foi tolerante aos danos desse problema.
O segundo passo para tentar elucidar o problema foi proceder com análises em laboratório para isolar e iden tificar os patógenos presentes nas vagens e sementes.
Contudo, até o presente momento, não se sabe os fatores e/ou agentes causais que poderiam estar asso ciados à anomalia de vagens. Assim, diante de todas
essas incertezas é de fundamental importância descartar ou confirmar a associação com patógenos.
Amostras de vagens e sementes de soja com sintomas da anomalia foram enviadas aos laboratórios para isola mento e identificação dos patógenos.
Para o experimento 1, utilizaram -se oito amostras de vagens e se mentes provenientes do município de Lucas do Rio Verde/MT, enviadas pela Fundação Rio Verde. Essas amos tras foram analisadas no Laboratório de Fitopatologia da Universidade de Passo Fundo, em Passo Fundo/RS, onde procederam-se a determinação da incidência de fungos nas vagens e sementes, o isolamento em meio de cultura, a obtenção de cultura pura e a identificação morfológica das estru turas reprodutivas dos fungos.
Para o experimento 2, foram ana lisadas seis amostras de vagens pro venientes dos municípios de Sapezal, Sorriso e Diamantino/MT, sendo con duzidas no Laboraratório de Manejo de Resistência da Syngenta, em Ho lambra/SP. Para isso, as vagens foram acondicionadas em câmaras úmidas para identificação das estruturas fún gicas, isolamento e crescimento em meio de cultura, e extração de DNA visando identificar o gênero dos fun gos por meio de sequenciamento da região ITS (região interna do espaça dor transcrito).
Como resultado do experimento 1, verificou-se que, após isolamento dos patógenos das vagens com sin tomas da anomalia, houve presença do fungo Cercospora em 98% das va gens, 45% de Colletrotrichum e 33% de Phomopsis. Para as sementes que estavam dentro das vagens, detectou -se a presença do fungo Cercospora em 27% das sementes, Macropho mina em 11%, Phomopsis em 9%, Fusarium em 7%, Colletotrichum em


1% e Corynespora em 1% (Figura 3A, 3B, 3C e 3D).



Sendo assim, os fungos Cercospo ra, Colletotrichum e Phomopsis foram detectados tanto nas vagens como nas sementes.
No experimento 2, onde outras amostras foram analisadas, o resul tado do sequenciamento da região ITS confirmou o gênero para todos os isolados de fungos. Nas amostras de vagens, verificou-se que 48% foram

identificadas como o fungo Colleto trichum, 33% como Cercospora, 16% com Phomopsis e 4% com Corynespora (Figura 4A, 4B, 4C, 4D e 4E).






Diante dos resultados similares dos dois experimentos, mesmo sen do executado de forma independente pelas instituições, nota-se que existem patógenos como Colletotrichum, Cer cospora e Phomopsis que ocorreram em ambos os experimentos, indicando que estes fungos podem estar asso ciados com o problema da anomalia de vagens.

Em algumas áreas do Mato Gros so que apresentaram ocorrência da anomalia, houve relato de produ tores, que o controle químico teria contribuído para minimizar o proble ma, isso provavelmente ocorreu em função do controle desses fungos. Por isso, a identificação precoce de
patógenos na lavoura e o controle químico eficiente são ferramentas importantes para evitar danos na produtividade e qualidade dos grãos da soja.
De maneira alguma esse assunto encerra-se com a publicação desses dados preliminares, pois esse pro blema pode ser uma associação de diversos fatores. A ideia é mostrar que fatores bióticos (fungos) estão as sociados com a anomalia e merecem aprofundamento da pesquisa.

Considerando a importância do tema para o produtor e para a cadeia produtora de soja, a aluna Monikéli Silva, doutoranda do curso de Pós-gra duação em Agronomia da Universida de de Passo Fundo, continuará com este estudo, buscando interação com pesquisadores de empresas públicas e privadas para gerar informação que

irá ajudar o produtor a evitar perdas e a manter a rentabilidade com a cul tura da soja.
Carolina Cardoso Deuner e Monikéli Aparecida da Silva, Universidade de Passo Fundo (UPF) Flávia Elis de Mello Sandra Marisa Mathioni Victoria Oasis Regis Lessa Matos Gustavo Cruz e Ricardo Francisco Desjardins Antunes, Syngenta Proteção de Cultivos
Figura 4 - Experimento 2: A, B, C e D) sintomas da anomalia de vagens da soja; E) visualização em estereomicroscópio (lupa) da esporulação de Colletotrichum e Cercospora na mesma vagem
2021/22 foi marcada por diversos desafios. No Sul do Brasil, o fenômeno la niña castigou as lavou ras de soja. Quedas de 56% e de 39% na produção foram registradas no Rio Grande do Sul e no Paraná, respectiva mente, ante cerca de 20 milhões de to neladas estimadas para cada estado no início da safra. No Centro-Oeste, Norte e Nordeste, por outro lado, as chuvas acima da média, dificultaram o controle fitossanitário, bem como a colheita de algumas lavouras. Aliado a isso, novos desafios, incluindo o “quebramento de plantas” e a “anomalia das vagens”, ainda de etiologia desconhecida, foram observados principalmente na região de Sorriso (MT).
A safra 2022/23 traz novos desafios a serem vencidos. Primeiro, a persistência da la niña gera apreensão aos produto res que semearam ou que em breve irão semear as lavouras de soja. Segundo, em função do abalo na cadeia de su primentos, efeito residual da pandemia da Covid-19 e da guerra entre Rússia e Ucrânia, os custos de produção aumen taram e alguns insumos estão em falta
no mercado, elevando o grau de dificul dade da nova safra. Do ponto de vista das doenças, compreender o comportamen to epidemiológico da última safra, bem como traçar perspectivas para a próxima safra, é determinante para assegurar a rentabilidade ao produtor.
Apesar da deficiência hídrica obser vada no Sul do Brasil, elevados volumes de chuva foram registrados no Oeste paranaense em outubro, com um acu mulado mensal de mais de 300mm. Neste caso, semeaduras realizadas en tre o final de setembro e o início de outubro, principalmente em solo com drenagem deficiente devido à compac tação, apresentaram elevadas perdas de estande. Diferenças significativas foram observadas entre cultivares; alguns ge nótipos, como M5947, apresentaram elevada incidência de tombamento de plântulas, enquanto baixa incidência da doença foi encontrada na cultivar Neo 610. Em alguns casos, o problema foi tão severo que houve necessidade de ressemeadura.
Um dos principais patógenos as
sociados à redução de estande foi o Phytophthora sojae. Esse oomiceto for ma esporos móveis dotados de flagelos (zoósporos) que se dispersam ativamen te em direção às raízes da soja, atraídos por exsudatos radiculares do grupo das isoflavonas. As condições ótimas para a doença incluem elevada umidade (so lo saturado), associada a temperaturas entre 25°C e 30°C. Os sintomas incluem uma podridão mole de coloração mar rom-clara nas raízes ou no hipocótilo, resultando na morte das plântulas, além de causar a podridão parda da haste em plantas adultas. Nas áreas onde foi observado esse problema, pelo fato de o patógeno permanecer no solo por longos períodos na forma de estruturas de resistência (oósporos), são de suma importância o emprego de cultivares resistentes, o uso do tratamento de se mentes com fungicidas que tenham boa ação contra oomicetos, além de um ma nejo que viabilize boa drenagem do solo.
Apesar do relato de tombamentos em semeaduras antecipadas, sem dúvi da, o principal fungo de solo que acome teu as plantas de soja na safra 2021/22 no Sul do Brasil foi Macrophomina pha

Figura 1 - Incidência da podridão de carvão em cultivares de soja na safra 2021/22. Santa Helena - PR, 2022. Fonte: Daniel Debona
Figura 2 - Concentração efetiva de fungicidas que inibe 50% o crescimento micelial (EC50) de isolados argentinos de Cercospora. Fonte: Adaptado de Sautua etal. (2020)


seolina (podridão de carvão), seguido por Fusarium (podridão vermelha da raiz). O fungo M. phaseolina sobrevive no solo na forma de microescleródios, estruturas de resistência que podem manter-se viáveis por vários anos. Além disso, o fungo apresenta uma ampla gama de hospedeiros, infectando mais de 500 espécies de plantas, incluindo o milho. Temperaturas elevadas (>30°C) e baixa disponibilidade hídrica, condições comumente observadas na última safra na região Sul, favoreceram a ocorrência da podridão de carvão. A limitação no aprofundamento radicular (compacta ção) é um dos principais fatores predis ponentes à doença.

Estudos realizados na última safra pe la Equipe ProteCrop da UTFPR - Campus Santa Helena mostraram que a incidên cia da podridão de carvão variou de acor do com a cultivar de soja empregada. Houve correlação negativa entre a du ração do ciclo e a incidência da doença, ou seja, cultivares com menores grupos de maturidade relativa mostraram-se mais suscetíveis à doença. As cultivares mais suscetíveis foram HO Pirapó, BMX Cromo e BMX Zeus, que apresentaram incidência acima de 85%. Em contrapar tida, as cultivares M5947 e M6110 i2X foram mais resistentes, apresentando incidência inferior a 35%. Considerando a alta incidência da podridão de carvão na última safra, a longevidade dos microes cleródios e o cultivo sucessivo de plantas hospedeiras (soja-milho), a próxima safra irá demandar especial atenção à doença. A associação de cultivares com maiores níveis de resistência, a manutenção de umidade no solo pelo plantio direto, o
manejo de solo visando à redução de camadas compactadas, além da aplica ção de agentes de biocontrole (Tricho derma), devem ser considerados como estratégias para mitigar o problema.
Em virtude da baixa disponibilidade hídrica da última safra, diversos produ tores acreditaram que seria um ano com poucas preocupações em termos de doenças foliares. Contudo, tal premissa revelou-se equivocada ao final da safra. Primeiro, porque a baixa disponibilidade hídrica observada nos meses de novem bro e dezembro estendeu a janela de semeadura, com semeaduras ocorrendo desde setembro até janeiro. Com isso, houve maior tempo para a multiplicação dos patógenos, acarretando severidades elevadas em lavouras semeadas tardia mente. Segundo, a baixa disponibilidade hídrica fez com que a maioria dos pro dutores flexibilizasse demasiadamente o programa de controle, deixando de realizar as aplicações em momentos oportunos. Nesta situação, os patóge nos encontraram uma planta com baixa capacidade de defesa, devido ao com prometimento fisiológico causado pela
falta de água, e ausência de proteção química devido à supressão das aplica ções de fungicida. Por conseguinte, com o retorno das chuvas a partir de feverei ro, as doenças evoluíram rapidamente, causando desfolha prematura e redu ções de produtividade que, em algumas situações, ultrapassam 15 sc/ha.
Várias lavouras de soja, especial mente durante a fase de enchimento de grãos (R5), apresentaram alto com prometimento da área foliar por man chas de coloração arroxeada de aspec to coriáceo, sintomas característicos do crestamento foliar por cercospora (Cercospora spp.), sendo essa a doença foliar mais prevalente na última safra na região Sul. O inóculo presente nas folhas foi transferido para os grãos, acarretan do alta incidência de mancha púrpura nos grãos. É importante ressaltar que nem sempre sementes infectadas pelo fungo apresentam sintomas da mancha púrpura, o que pode indicar que o nível de inóculo esteja sendo subestimado. Dessa forma, a presença de Cercospora nas sementes e nos restos culturais im plica elevada oferta de inóculo primário do fungo para a próxima safra. Além de ser resultado da flexibilização dos pro
gramas de controle, com início tardio e intervalos distendidos, o aumento na se veridade da doença pode ser explicado pela dificuldade de controle que alguns ingredientes ativos e grupos químicos têm apresentado.

Estudos realizados no Brasil e na Ar gentina têm evidenciado uma menor sensibilidade do fungo a fungicidas. Na Argentina, isolados de Cercospora foram sensíveis a fungicidas do grupo dos tria zóis, porém houve grande variação na inibição do crescimento micelial do fun go pelos diferentes ingredientes ativos; difenoconazol foi o mais fungitóxico, en quanto ciproconazol apresentou menor fungicitoxidade (Figura 2; Sautua et al., Plant Pathology 2020; 69:1678-1694). Embora o fungicida carbendazim tenha apresentado elevada fungitoxidade, me tade dos isolados foi resistente (mutação E198A) a esse ingrediente ativo, o que, aliado ao seu recente banimento, desa bona o uso para o controle de doenças na cultura da soja. Um fato preocupante é que todos os isolados de Cercospora foram resistentes ao grupo das estrobi lurinas, a maioria deles apresentando a mutação G143A, e insensível a carbo xamidas. Portanto, o crestamento foliar por Cercospora deve continuar aumen tando em importância em toda a Amé rica do Sul, exigindo medidas como uso de sementes de boa qualidade sanitária e tratadas com fungicidas, complemen tadas com aplicações em parte aérea contendo ingredientes ativos eficientes, combinando fungicidas sítio-específicos e multissítios eficientes no controle do crestamento foliar por Cercospora.
Elevada severidade da mancha-alvo (Corynespora cassiicola) e da antracnose (Colletotrichum cliviae e C. truncatum), essa última principalmente em vagens, foi registrada em muitas lavouras do Cerrado brasileiro. A mancha-alvo tem se consolidado como a principal doença
foliar dessa região, em virtude do uso de cultivares suscetíveis, monocultura de soja e algumas sucessões com culturas hospedeiras de C. cassiicola, entre elas o algodão e a crotalária. No Sul do Brasil, a mancha-alvo também tem aumentado em prevalência, principalmente em regi ões de menores altitudes quando ocor rem períodos com elevada umidade, como registrado em janeiro de 2021 na região Oeste do Paraná. Em regiões onde a mancha-alvo é a doença prevalente, a escolha de cultivares menos suscetíveis, aplicações durante a fase vegetativa e inclusão do ingrediente ativo protioco nazol no programa são de suma impor tância para o sucesso no controle da doença. Aplicações ainda mais precoces são demandadas quando a antracnose estiver no radar do controle.

A ferrugem-asiática (Phakopsora pachyrhizi) ainda constitui a principal preocupação dos produtores de soja. No entanto, a adoção do vazio sanitá rio, a semeadura no início da época re comendada e o emprego de cultivares de ciclo precoce têm reduzido a impor tância relativa da doença. Na região Sul, a baixa frequência de chuvas limitou o avanço da doença nas lavouras se meadas entre setembro e novembro, com pouco impacto na produtividade. Por outro lado, lavouras semeadas en tre dezembro e janeiro apresentaram perdas de produtividade significativas devido à doença. A extensa área de cultivo de soja de segunda safra no Paraguai (>um milhão de hectares), a manutenção de plantas voluntárias na entressafra, bem como a ampla janela de semeadura da safra corrente devido à eventual impossibilidade de semea dura antecipada pela deficiência hídrica ou pelo cultivo de trigo no Sul podem resultar em aumento na importância da doença para a próxima safra nesta região.

O cenário de doenças na cultura da soja tem sido bastante desafiador, com forte influência do local e do ano. Além disso, alterações no manejo agronômi co e nas características dos materiais de soja (materiais cada vez mais precoces, novos eventos biotecnológicos, maior sensibilidade a manchas foliares) têm alterado a dinâmica populacional dos patógenos, trazendo novos desafios.
No Sul, a safra 2021/22 evidenciou que, apesar do ano seco, o manejo de doenças não deve ser negligenciado sob pena de comprometer a rentabilidade da atividade agrícola.
No Centro-Norte, por outro lado, as chuvas trouxeram dificuldades operacio nais para a realização do controle fitos sanitário em momentos oportunos. A falha de controle observada em diversas lavouras ao longo do País na última sa fra traz sérias preocupações para a pró xima temporada, uma vez que diversos agentes causadores de tombamento e de manchas foliares tiveram seu inóculo aumentado. A “ponte verde” resultante da inobservância do vazio sanitário e a dilatação da janela de semeadura po dem agravar o problema com doenças, principalmente relacionado à ferrugem -asiática.
Dessa forma, a escolha de cultivares menos suscetíveis, uma boa cobertura do solo, o tratamento de sementes com fungicidas químicos, o uso de produtos biológicos, o momento de entrada com os fungicidas, a escolha e o seu posicio namento tornam-se primordiais para o êxito no manejo de doenças.
Vagem de soja com sintomas da antracnose observados na safra 2020/21. Santa Helena – PR, 2022
Noano de recorde de área plantada de soja, quase 40 milhões de hectares, o sojicultor não tem muitos motivos para comemorar. Nunca na história houve tantos desafios em uma safra. De desafios operacionais, como falta de insumos a climáticos, como a seca do Sul do Brasil e o recente desafio de controle de novas plantas daninhas resisten tes aos herbicidas.
Detectada inicialmente em dezembro de 2018 (Oliveira et al., 2019), o Amaranthus hibridus é uma planta daninha de altíssima multiplicação e de fácil dispersão. Já presente na Argentina e no Uruguai, acredita-se que as sementes possam ter sido importa das pelas zonas agrícolas de fronteiras no Rio Grande do Sul, via transporte de insumos ou máquinas.

A discussão sobre a entradas de plantas resistentes pelas fronteiras é muito importante, visto que na Argentina o A. hibri dus tem resistência múltipla aos herbicidas inibidores da EPSPS (glifosato), ALS (chlorimuron-ethyl) e auxinas (2,4-D e dicamba) (Heap, 2020), porém é uma discussão para outro momento.
Neste momento, a grande discussão é em relação à possibi lidade de cruzamento do A. hibridus resistente com as espécies mais comuns no Brasil que já apresentam resistência a herbici das, neste caso A. retroflexus e A. viridis (Tabela 1). Neste quesito, ainda está cedo para muitas afirmações, mas já se sabe que há grande chance de cruzamento entre essas espécies diferentes

Tabela 1 - Principais espécies de Amaranthus com resistência
Amaranthus
reportadas
Atrazina, Prometrina e Fomesafem
Atrazina e Prometrina
Clorimurom,
dos Amaranthus existentes em todo o território e a transferência da resistência a glifosato (Gaines et al., 2012) para ou tras espécies, fazendo assim que novas combinações de resistência surjam no campo, levando a uma grande “salada” de combinações de resistência aos her bicidas, deixando ainda mais complexo o manejo dessas plantas daninhas.

Na safra 21/22 há relatos de agricul tores da presença de plantas de Amaran thus sobrevivendo ao herbicida glifosato em sete estados brasileiros. Em uns com alta frequência, como no Rio Grande do Sul, que já tem propriedades com mais de 40%. Em outros, ainda com baixa frequência, como em Goiás, com áreas abaixo de 0,5% de infestação. De qual quer forma, a sobrevivência plantas de Amaranthus em campo onde se usou o herbicida glifosato explodiu nas ultimas quatro safras, mostrando a extraordiná ria capacidade de dispersão dessa planta daninha (Figura 1).
Em um recente trabalho publicado (Mathioni et al., 2022), confirmou-se que é possível encontrar plantas segre gando para a resistência ao herbicida glifosato, isso se deve quase sempre ao cruzamento de plantas resistentes com plantas sensíveis. Como isso impacta pa ra a vida do agricultor?
Na prática, temos dois desdobra mentos para essa informação.
A primeira, é que plantas homozi góticas, ou seja, que apresentam a pre sença completa dos genes de resistência a glifosato, são as que apresentam alta resistência ao herbicida glifosato. Há re latos de plantas sobrevivendo a 64 vezes a dose de campo do herbicida glifosato (Figura 2).
O outro desdobramento é a combi nação da resistência do glifosato com resistências a outros herbicidas pelo cruzamento com outras plantas, que pro vavelmente serão detectadas em breve,
levando a situações de resistências múl tiplas, como as encontradas na Argenti na e nos EUA, onde é possível observar plantas segregando para várias resis tências. Com isso, inviabilizam de um a quatro grupos químicos dos herbicidas.
Frente a esse cenário preocupante, focar nas ações de manejo que precisam ser implementadas imediatamente nas regiões onde já foram detectadas plan tas resistência a glifosato é primordial. Há diversas estratégias de manejo das plantas daninhas, sendo elas resistentes ou não. Porém, no caso da presença de resistência, há um aumento da dificul dade da implementação. O manejo das plantas daninhas através de herbicidas precisa ter uma atenção redobrada, para evitar que o problema se agrave com o uso de um herbicida que leve um au mento da resistência, para isso, a reco mendação é sempre se buscar herbici das que possam atuar em mecanismos distintos de ação.
No caso dos Amaranthus, o uso de herbicidas pré-emergentes e com residual são os mais recomendados. No recente trabalho de Pedroso et al., 2020, os autores demonstram que há diferenças significativas dos herbicidas pré-emergentes com base no sistema de aplicação adotado, demonstrando que, de forma geral, o sistema plante e
aplique apresenta melhor controle so bre as plantas de Amaranthus quando comparado ao sistema aplique e plante (Tabela 2).
Informações como as apresentadas por Pedroso et al. trazem à tona uma série de questões técnicas que precisam ser dominadas para enfrentar o Amaran thus de forma mais efetiva. Conhecimen tos do tipo de solo, umidade do solo no momento de aplicação e presença ou não de palhada são somente alguns itens que precisam estar em alinhamento com o uso de herbicidas pré-emergentes, pa ra se ter um excelente controle de Ama ranthus resistente na lavoura.
Além de todos esses pontos, práticas rotineiras não podem ser deixadas de lado, como uso de sementes certificas de boa origem, limpeza do maquinário agrícola, principalmente colheitadeiras, e um adequado sistema de tecnologia de aplicação, pois vêm somar na boa prática para o controle dessa importante planta daninha.
Daniel D. Rosa, AgPlant – Consultoria e Serviços Agronômicos
Tabela 2 - Controle de Amaranthus spp. com herbicidas pré-emergentes em dois sistemas
aplicação. Adaptado de Pedroso etal., 2020
Diclosulam
Os sistemas de produ ção de grãos da região Centro-Oeste consti tuem um ambiente favorável para o estabelecimento de pragas, pois prevalece o cultivo do milho em áreas extensivas tanto no período de verão quanto na safri nha, além do cultivo de plantas de cobertura entre o cultivo de inverno e o de verão. Com a expansão da cultura do milho para novas regiões agrícolas, tem-se observado um nú mero crescente de pragas que ata cam as plântulas. Veja-se:

• Lagartas na cobertura: diver sas lagartas já estão normalmente presentes na cultura utilizada como cobertura no Sistema Plantio Direto (SPD) e que será dessecada para a semeadura do milho, especialmente para o milho cultivado no período de verão. Essa cobertura vegetal é destinada à produção de palha no SPD (exemplo: aveia, trigo e braqui
ária), mas pode também proporcio nar o desenvolvimento de altas po pulações de lagartas, especialmente da espécie Spodoptera frugiperda, nos períodos mais secos do ano.
Caso a semeadura seja realizada imediatamente após a dessecação da cobertura, as lagartas presentes na área, se não forem controladas, po dem cortar as plantas do milho rente ao solo ou alimentar-se de sua folha gem, podendo causar a sua morte e, consequentemente, a redução do estande da cultura. Além de S. frugi perda, outras espécies, como S. eri danea, S. cosmioides, Mocis latipes e até mesmo a lagarta-rosca, Agrotis ípsilon, podem ocorrer.
• Lagarta-elasmo (Elasmopal pus lignosellus): a lagarta-elasmo é uma praga que pode danificar as plantas jovens de milho, especial mente quando o inseto já estiver presente na cobertura a ser desse cada para a semeadura da cultura.
O inseto é considerado polífago, ou seja, alimenta-se de diversas espé cies de plantas cultivadas, silvestres e daninhas, em especial aquelas pertencentes ao grupo das gramí neas e leguminosas. O adulto faz a postura nas plantas de milho ou em restos culturais presentes na área. Após a eclosão, as larvas alimentam -se inicialmente de matéria orgâni ca ou raspando o tecido vegetal e, em seguida, penetram no colo da planta de milho, um pouco abaixo do nível do solo, onde constroem uma galeria ascendente. Próximo ao orifício de entrada, as larvas tecem um casulo formado de excrementos, restos vegetais e partículas de ter ra, sinais estes que caracterizam a presença da praga na lavoura. Uma mesma lagarta pode atacar até três plantas de milho durante a sua fa se larval, da emergência até aos 30 dias de desenvolvimento das plan tas, período este considerado o mais
Na cultura do milho, o manejo de algumas pragas deve ser iniciado no momento em que é realizada a dessecação da espécie anteriormente cultivadasuscetível à lagarta-elasmo.
O ataque dessa praga causa o sintoma denominado de “coração morto”, caracterizado pelo murcha mento das folhas centrais, as quais se destacam facilmente quando puxadas, causando a obstrução no transporte de água e de nutrientes do solo para a parte aérea da planta. Nestes casos, pode ocorrer a morte da planta, reduzindo o estande da cultura ou o perfilhamento, o que torna a planta improdutiva. A inten sidade de danos da lagarta-elasmo no milho é maior e mais frequente em condições de alta temperatura e de déficit hídrico no solo, especial mente em solos arenosos ou mistos conduzidos em plantio convencio nal, como frequentemente ocorre na região do Cerrado brasileiro.
• Percevejos barriga-verde: as espécies Diceraeus melacanthus e D. furcatus, embora sejam relatadas como pragas secundárias da soja em várias regiões do Brasil, vêm sendo encontradas em lavouras de milho do país desde a década de 1990. Os insetos apresentam a parte dor sal marrom e a ventral verde, daí o nome barriga-verde. Os ovos, de coloração verde azulada, são coloca dos sobre as folhas do milho ou até mesmo de plantas daninhas. Duran te a alimentação, esses percevejos posicionam-se, normalmente, no sentido longitudinal da planta, com a cabeça orientada para a região do



colo. Se, no processo de alimenta ção, o meristema apical for danifi cado, as folhas centrais da plântula murcham e secam, manifestando o sintoma denominado “coração morto”, podendo também ocorrer o perfilhamento ou a morte da plan ta.
Se o meristema apical não é danificado, as primeiras folhas que se desenrolam do cartucho apre sentam estrias esbranquiçadas transversais, muitas vezes com per furações de halo amarelado, prove nientes das punções que o inseto fez durante a alimentação na base da planta ainda jovem. Quando as
folhas do cartucho não conseguem se desenrolar, conferem um aspecto de “encharutamento” na planta. Os danos causados por percevejos no milho têm sido mais acentuados na época de cultivo safrinha, uma vez que o inseto se multiplica no verão, no final do ciclo da soja.
Vale ressaltar que além do barri ga-verde, outras espécies de perce vejo como Euschistus heros e Nezara viridula podem atacar as plântulas de milho, porém com menor capaci dade de causar danos, quando com parado ao barriga-verde.
• Cigarrinha-do-milho: a cigar rinha-do-milho, Dalbulus maidis, é
Atualmente a cigarrinha-do-milho é considerada uma praga-chave do milho pela transmissão dos patógenos responsáveis pelas doenças comumente conhecidas como enfezamentos
um inseto sugador pertencente à família Cicadellidae. Apresenta qua tro fileiras de espinhos nas tíbias das pernas posteriores, coloração amarelo-palha, mede de 3,7mm a 4,3mm de comprimento e apresenta duas manchas circulares negras facil mente visíveis na parte dorsal da ca beça, entre os olhos compostos, ca racterística que facilita a sua identifi cação no campo. O inseto apresenta também o comportamento de se deslocar lateralmente sobre a planta quando perturbado e é encontrado preferencialmente no interior do cartucho das plantas de milho.


Atualmente, a cigarrinha-do -milho é considerada uma praga -chave do milho pela transmissão dos patógenos responsáveis pelas doenças comumente conhecidas co mo enfezamentos. Os enfezamentos são doenças provocadas por duas bactérias, denominadas fitoplasma, que causam o enfezamento verme lho, e espiroplasma (Spiroplasma kunkelii), responsáveis pelo enfeza mento pálido, sendo que ambos os patógenos ocorrem no floema e são transmitidos de forma persistente pela cigarrinha. Essas duas doenças são consideradas hoje como prin cipais desafios fitossanitários da cadeia produtiva do milho no Brasil. Além dos enfezamentos, a cigarrinha pode transmitir os vírus responsá veis pelas doenças chamadas virose da risca e virose do mosaico estriado do milho.
Os enfezamentos (vermelho e pálido) são doenças sistêmicas vas culares que se alojam e colonizam os vasos condutores (floema) do milho, provocando desordens fisiológicas, hormonais e bioquímicas, que se refletem em sintomas foliares e na formação das espigas menores e deformadas, prejudicando assim o desenvolvimento da planta e, con sequentemente, reduzindo a sua produtividade da cultura. Embora D. maidis possa ocorrer durante todo o ciclo da cultura, nós consideramos essa espécie como praga de plântu las, uma vez que essa fase de desen volvimento do milho é a mais susce tível ao ataque da cigarrinha. Depen dendo das condições do ambiente, do híbrido utilizado e da idade em que as plantas são infectadas, essas doenças podem provocar perdas ex pressivas, e quanto mais precoce for a infecção da planta pelos patógenos, maiores serão os danos na cultura.
O manejo integrado de pragas (MIP) em milho deve ser iniciado antes do plantio, por ocasião da des secação da espécie utilizada no SPD. Nesse momento é necessário fazer uma pergunta: existem lagartas na cobertura a ser dessecada?
Para responder isso é necessário amostrar as plantas da cobertura. Em caso negativo, deverá ser feita a pul verização apenas com o herbicida pa
ra dessecar a cobertura e nunca adi cionar inseticidas. No entanto, caso haja presença de lagartas na cober tura, e se a semeadura for realizada logo após a dessecação, recomenda -se então aplicar um inseticida (la garticida) em pulverização com alto volume (mínimo 150L/ha). Devemos utilizar produtos que tenham pouco ou nenhum efeito sobre os inimigos naturais (predadores, parasitoides e entomopatógenos), como as dia midas, as spinosinas e os produtos fisiológicos.
Para a lagarta-elasmo, tem sido comprovado que chuvas bem dis tribuídas, durante os primeiros 30 dias de desenvolvimento da cultura, praticamente eliminam a infesta ção desse inseto nas lavouras. No sistema plantio direto, que propicia melhor conservação da umidade do solo, essa praga tem ocorrido em menor intensidade quando com parado ao sistema convencional. A pulverização de inseticidas na parte aérea do milho tem proporciona do baixa eficiência de controle da lagarta-elasmo (< 50%), em razão da posição em que a praga fica alo jada na planta. O tratamento das sementes do milho com inseticidas sistêmicos, especialmente conten do neonicotinoides isolados ou em mistura com piretroides, carbamatos ou diamidas, tem se mostrado uma tática eficiente para o controle da lagarta-elasmo.
O controle do percevejo barriga
-verde pode ser realizado preventi vamente, empregando-se inseticidas nas sementes ou em pulverização sobre as plântulas. O período de maior cuidado com o percevejo é durante a fase inicial de desenvol vimento da cultura, entre a emer gência e o surgimento da quarta folha aberta (V4), que corresponde à idade entre 15-20 dias após a emer gência das plantas. Cabe-se ressaltar que é durante essa fase de desenvol vimento que a planta de milho defi ne o seu potencial produtivo.
Antes de realizar a semeadura do milho, recomenda-se fazer uma inspeção na área em que a lavoura será implantada, visando constatar a presença de ninfas e de adultos do percevejo barriga-verde, para avaliar a necessidade ou não de se tratar as sementes ou até mesmo de efe tuar uma pulverização com insetici da após a emergência das plantas. Os inseticidas recomendados, em pulverização, para o complexo de percevejos fitófagos da soja são nor malmente eficientes no controle do percevejo barriga-verde, no milho. Trabalhos conduzidos na Embrapa Agropecuária Oeste evidenciaram que o nível de dano para o controle do percevejo-barriga-verde no mi lho safrinha é inferior a um inseto para cada cinco plantas de milho na lavoura.
Para o manejo das populações da cigarrinha D. maidis e dos enfe zamentos na cultura do milho são recomendadas diversas práticas agrícolas, essencialmente de caráter preventivo, as quais são baseadas nas táticas de controle químico, bio lógico e cultural. É desejável que es sas práticas de controle sejam ado tadas de forma conjunta tanto em nível de propriedade quanto da re gião produtora. A fase inicial de de senvolvimento do milho é considera da o período crítico para o controle da cigarrinha, uma vez que quanto mais precoce ocorrer a infecção das plantas, maiores serão os prejuízos à produção.

O controle eficiente do milho ti guera, durante o cultivo de soja no

verão, é uma das estratégias mais importantes para a redução popula cional da cigarrinha e dos patógenos por ela transmitidos nos cultivos do milho safrinha. Além do milho tiguera, o cultivo de milho verde para consumo humano em chácaras e sítios na região contribui para o desenvolvimento populacional da ci garrinha-do-milho e das doenças as sociadas a ela. Além disso, a colheita bem-feita e o transporte adequado do milho reduzem a possibilidade de surgimento de plantas de milho tiguera nas áreas de produção e nas rotas de transporte dos grãos.
O controle químico da cigarrinha -do-milho pode ser realizado por meio do tratamento das sementes e em pulverizações foliares nas fa ses iniciais de desenvolvimento da cultura (entre a emergência e a fa se V8). O tratamento de sementes industrial tem sido mais adequado quando comparado ao tratamento de sementes feito pelos próprios produtores em suas propriedades (on farm), em razão da maior preci são e da uniformidade da dose do inseticida aplicado nas sementes. No caso de pulverização, é impres cindível o monitoramento das popu lações da cigarrinha nas plantas de milho para verificar a necessidade ou não do seu controle. O uso de patógenos, como Beauveria bassia na ou Isaria fumosorosea, aplicados em pulverização tem se tornando uma ferramenta importante para o manejo da cigarrinha. A implemen
tação exclusiva de um único método de controle não garante um manejo eficaz do inseto-vetor e das doenças transmitidas por ele na cultura do milho. A associação de inseticidas químicos e biológicos tem proporcio nado uma melhor performance na eficiência de controle da cigarrinha quando comparada à utilização dos produtos isoladamente.
Os híbridos comerciais de milho apresentam diferentes graus de resis tência/tolerância aos enfezamentos. Dessa forma, a utilização de híbridos mais resistentes/tolerantes a essas doenças pode também reduzir os riscos de perdas na produção. Estu dos têm demonstrado que, sob as mesmas condições, alguns híbridos podem apresentar menos de 10% de incidência de enfezamentos, enquan to outros podem atingir mais de 65% de plantas infectadas.
C
Crébio José Ávila, Embrapa Agropecuária Oeste Charles Martins de Oliveira, Embrapa Cerrados Ivana Fernandes da Silva, Universidade Federal da Grande Dourados
A lagarta-elasmo é uma praga que pode danificar as plantas jovens de milho, especialmente quando o inseto já estiver presente na cobertura a ser dessecada para a semeadura As lagartas já estão normalmente presentes na cultura utilizada como cobertura no Sistema Plantio Direto (SPD) e que será dessecada para a semeadura do milhoAlém de realizar a correção, é fundamental ajustar a dose de acordo com as necessidades do solo baseado no laudo
Um solo fértil é capaz de suprir a demanda de nu trientes das culturas no tempo e na intensidade adequados para que as plantas possam expressar o máximo potencial produti vo. Técnicas de melhoria da fertilidade do solo são estudadas há muito tempo e apresentaram, juntamente com o melhoramento genético, dois dos pila res mais importantes para os aumen tos de produtividade visualizados nas últimas décadas.
Uma dessas técnicas de melhoria da fertilidade dos solos é a calagem. Essa foi uma das práticas agrícolas de maior relevância para o aumento da produtividade e a incorporação de so los ácidos na área produtiva do Brasil. A calagem visa ao aumento dos teores de cálcio (Ca) e magnésio (Mg) do solo, neutralizar espécies tóxicas de alumí nio (Al) às plantas e ajustar o pH do so
lo para faixas em que a disponibilidade dos nutrientes necessários às plantas é adequada.
Visto a grande importância da cala gem, campanhas de adoção em massa dessa prática, como a operação tatu no RS, a operação fertilidade em SC, entre outras, foram fomentadas pela pesqui sa e extensão aos agricultores no pas sado. De maneira geral, grande parte do território nacional possui solos pre dominantemente ácidos, característica que os torna de aptidão natural baixa para a maioria dos cultivos agrícolas. A calagem foi a grande responsável pela abertura de novas fronteiras agrícolas no País, além do aumento da produtivi dade em áreas que já estavam incorpo radas aos sistemas produtivos.
A quantidade a ser aplicada e a frequência de uso do calcário em uma área agrícola sempre devem ser alicer çadas na análise de solo. Através da

análise do solo pode ser indicado de maneira racional, além da dose, o tipo de calcário a ser utilizado visando a equilibrar os níveis de Ca e Mg do solo. O método de cálculo varia de acordo com a região, podendo ser utilizada por exemplo a saturação por bases, o índice SMP ou os teores de Al, Ca e Mg trocá veis para determinar a dose de calcário necessária para a correção do solo, devendo sempre ser seguido o método validado e calibrado para a região agrí cola em questão.
Um ponto importante quanto às doses de calcário é que com o advento da semeadura direta na palha os pro dutores deixaram de revolver o solo, e o calcário que antes era incorpora do por meio de aragem e gradagens passou a ser aplicado na superfície do solo. Com a mudança dessa dinâmica as recomendações de calagem passa ram a ter sua dose reduzida à metade
do indicado para correção do solo até 20cm de profundidade. Aliado a isso, o aumento na intensidade de uso do solo com duas a três safras por ano, o uso de elevadas doses de fertilizante (principalmente os nitrogenados) e os processos naturais de decomposição dos resíduos vegetais tendem a acidifi car os solos agrícolas.
Os solos possuem resiliência e devido à característica natural de aci dez tendem a voltar ao seu estado de origem. Esses fatos têm sido experi mentados por produtores da região deste estudo, que aplicando as doses recomendadas de calcário observavam que rapidamente (18 a 24 meses após a aplicação) o pH e saturação por bases de seus solos estavam em teores idên ticos aos iniciais. Além disso, resultados de projetos para aumento da produti vidade das culturas, como o concurso promovido pelo Comitê Estratégico Soja Brasil (Cesb), têm demostrado que frequentemente as maiores produti vidades dessa cultura estão atreladas a solos corrigidos em profundidades
A calagem foi a grande responsável pela abertura de novas fronteiras agrícolas no País, além do aumento da produtividade em áreas que já estavam incorporadas aos sistemas produtivos

superiores a 20cm, o que demandaria doses mais elevadas de corretivos. Em função disso, e por questões operacio nais que travam a reaplicação frequen te dos corretivos, realizou-se um estu do com o objetivo de identificar se as doses utilizadas seguindo a recomen dação seriam suficientes para suportar altos índices produtivos.
O experimento foi realizado no Centro de Pesquisa Agrícola da Copacol (CPA), no município de Cafelândia – PR,

no período de outubro de 2018 a agos to de 2020. A área em estudo possui altitude de 580m e solo com teor de argila de 68%. Uma análise de solo foi coletada na área antes da implantação do experimento, em agosto de 2018.
Os resultados da análise de solo aplicando o método recomendado para o estado do Paraná, elevação da saturação por bases para 70% na ca mada de 0cm-20cm e aplicação em superfície (metade da dose), indicaram
uma dose de 1.800kg/ha de calcário dolomítico com PRNT de 70%. A satu ração inicial estava em 50% e a CTC do solo, em 13Cmolc/dm³.




A partir desses dados foram defi nidos cinco tratamentos (T), sendo T1 uma testemunha sem aplicação de cal cário (0), T2 usando a dose recomen dada atualmente com a divisão por dois 1.800kg/ha (50%), T3 usando a dose necessária para corrigir o solo até 20cm, 3.600 kg/ha (100%), T4 usando a dose recomendada para correção até 30cm, 5.400 kg/ha (150%), e T5 usan do a dose recomendada para correção até 40cm, 7.200kg/ha (200%).
Em todos os tratamentos a cor reção foi realizada com aplicação do calcário em superfície 30 dias antes da semeadura do primeiro cultivo. Os tratamentos foram arranjados em de lineamento de blocos completamente casualizados com quatro repetições. As parcelas possuíam 5m de largura por 14m de comprimento. As culturas, cultivares, doses de fertilizantes podem ser observadas na Tabela 1.


Realizou-se uma análise de solo ao final da quarta safra, considerando a camada de 0cm a 20cm de profundi dade. Os resultados estão descritos na Tabela 2. Observa-se que, apesar dos maiores teores de Ca e Mg e satura
ção por bases nos tratamentos com aplicação de calcário mesmo na dose de 100% utilizada para corrigir o solo até 20cm, a saturação por bases está semelhante à observada inicialmente antes da implantação do experimen to. Isso demonstra o elevado grau de acidificação do solo em sistema de cul tivos intensivos. Nessa condição seria necessária uma reaplicação do correti vo após a quarta safra.
No primeiro cultivo (soja 18/19), as condições para o desenvolvimen to da cultura foram satisfatórias. Nessa safra, não foram observadas diferenças significativas entre os tra tamentos, função essa da boa condi ção hídrica e do curto período para reação do calcário, já que o mesmo foi aplicado somente 30 dias antes da semeadura da soja, quando o reco mendado seriam pelo menos 90 dias. Houve restrições hídricas para as cul turas em três safras, exceto a primei ra. O estresse mais severo foi obser vado no terceiro cultivo, em função principalmente da antecipação da semeadura da soja, prática muito co mum na região. O menor rendimento da safra de soja 19/20 está atrelado a esse estresse.
Na Figura 1, é possível observar o rendimento de cada cultura e o ren
dimento somado das quatro safras. Evidenciando a resposta das doses de calcário de 100% e 150%. No cul tivo de milho segunda safra (2020), a maior produtividade foi observada no tratamento com 150% da dose de calcário, esse resultado pode estar atrelado ao efeito residual da maior dose, visto que o solo tende a voltar ao estado natural conforme discutido anteriormente.
Considerando o preço de venda das culturas na data da colheita, multiplica do ao rendimento obtido, realizou-se um índice de receita bruta (R$/ha). Os valores considerados para esse cálculo foram de R$ 68,00, R$ 47,00, R$ 85,5 e R$ 50,00 por saca de soja (2019), tri go (2019), soja (2020) e milho (2020), respectivamente. Os dados de renta bilidade bruta acumulada podem ser observados na Figura 2.
Quando considerados o rendimen to e a rentabilidade bruta acumulada das quatro safras (gráficos a seguir), observa-se uma regressão de segundo grau com ponto de máxima nas doses de 135% e 129%, respectivamente. Os dados demonstram uma melhor res posta ao uso de doses mais elevadas que o recomendado atualmente.
Os dados da análise de solo ao fi nal do experimento corroboram com as observações em áreas comerciais de produtores da região, que verifi cam retorno das características iniciais em um curto espaço de tempo com a aplicação das doses recomendadas pelos métodos atuais para o Oeste do Paraná. Para as culturas trabalhadas no experimento, a saturação por bases adequada na camada de 0cm-20cm seria de 70%, com um mínimo de 55%. Observa-se que apenas nas duas do
Tabela 1 - Informações referente às safras avaliadas no experimento
Safra
Cultura
Cultivar
Fertilizante (kg/ha)
Fórmula (N-P2O5-K2O)
Semeadura (data) População (plantas/m2)

2018/2019
Soja M 5947 IPRO 300 04-24-16 22/10/2018 22
2019/2019
Trigo TBIO Toruk 310 10-15-15 08/05/2019 300
2019/2020
Soja BMX Lança Ipro 350 04-23-18 16/09/2019
2020/2020 Milho AS 1633 PRO3 310 10-15-15 28/01/2020 6
Tabela 2 - Dados da análise de solo coletada após os quatro cultivos na profundidade de 0 a 20 cm, Cafelândia-PR 2020
Magnésio
Saturação por bases
ses mais elevadas a saturação ainda está próxima do mínimo desejado 24 meses após a aplicação do corretivo. Apesar dos teores baixos de alumínio mesmo na testemunha sem calagem (característica natural do solo), o aumento dos teores de Ca e Mg e do pH do solo favoreceu as culturas ampliando seu rendi mento.
É evidente a importância da correção da acidez do solo para o aumento de rendimento, os dados do experimento con firmam isso. O incremento de produtividade de cada cultura pode ser considerado baixo no experimento se analisado indi vidualmente, porém como a aplicação de corretivos apresenta benefícios para mais de um cultivo, quando analisado o soma tório das quatro safras fica claro o benefício dessa prática para as culturas avaliadas.
Além de realizar a correção, é fundamental ajustar a dose de acordo com as necessidades do solo baseado no laudo. No experimento é possível observar que a produtividade até a terceira safra o rendimento somado das doses de 50%, 100% e 150% é similar (174 e 179 e 170 sc/ha, respectivamente), po rém no cultivo de milho houve maior rendimento nas doses de 100% e 150%. Isso indica que a dose de 50% que hoje é utiliza da pode necessitar de reaplicação com maior frequência, pois no último cultivo o rendimento de grãos foi similar à testemu nha sem correção.

Outro aspecto observado, é que a maior dose (200%) apre sentou baixo incremento no rendimento, além de propiciar
ajuste quadrático negativo na equação da Figura 2. Esse dado corrobora com outros trabalhos, demonstrando que doses ele vadas de calcário (“supercalagem”), podem apresentar baixa resposta e/ou redução de produtividade em algumas situações. Diante disso, o uso indiscriminado de elevadas doses de calcá rio pode ocasionar a indisponibilização de alguns nutrientes, principalmente micronutrientes metálicos. Além disso, em pH elevado pode ocorrer fixação do fósforo às moléculas de cálcio no solo. Seja para recomendação ou monitoramento dos níveis de fertilidade, sempre deve ser considerada a análise de solo.

É importante ressaltar que, apesar de avaliado em quatro safras, esses resultados são referentes somente a um tipo de solo e região, não devendo ser levados como recomendação generalizada. Apesar disso, os resultados sugerem novos es tudos para revisar dos parâmetros adotados para calagem do solo em semeadura direta na palha em sistemas intensivos de cultivo em cada região.
C Ariel Muhl João Mauricio Trentini Roy Tiago Madalosso Gabriele Larissa Hoelscher Ana Claudia C. Nogueira e Vanei Tonini, CPA Copacoldezenas de milhares de anos os seres humanos vêm domesticando e modificando plantas e animais, para aten der às necessidades humanas. Nas últimas décadas, o ganho de rendimento médio das plantas que produzem grãos tem sido de 1% ao ano. Agora, os cientistas contam com ferramentas avançadas para acelerar a obtenção de resultados.
Uma simples modificação genética possibilita duplicar o número de grãos do sorgo. O estudo da equipe liderada pelo doutor Yinping Jiao (bitly.ws/thfh) utilizou genótipos de sorgo de alto rendimento, submetidos à mutação induzida por uma substância química.
Os grãos de sorgo são produzidos em cachos de flores que se desenvolvem em uma estrutura ramificada, no topo da planta, chamada panícula. Cada panícula produz centenas de flores. Existem dois tipos de flores e, geralmente, apenas uma delas, a espigueta séssil, é fértil. As espigue tas pediceladas não produzem sementes. Nas plantas modificadas por mutagênese, tanto espiguetas sésseis quanto pedicela das produziram sementes, duplicando o número de grãos de cada planta.
Pelo sequenciamento dos genomas das plantas de sorgo, convencionais e modifica das, foi descoberto que a mutação afetou um gene que regula a produção de um hor mônio, o ácido jasmônico (AJ). As plantas mutantes produzem níveis mais baixos de AJ durante o desenvolvimento da flor. O AJ impede que as espiguetas pediceladas produzam sementes. Com redução de 50% no teor de ácido jasmônico, a planta pro duz grãos em ambas as flores. Logo, basta modular a expressão do gene responsável pela produção de AJ para aumentar a pro dutividade do sorgo.
Ademais, algumas das plantas deriva das de mutantes, com alta produtividade, também aumentaram o teor de proteína do grão em 14%-24%, o que melhora mui to a qualidade nutricional do sorgo (bitly. ws/thmw).
A mesma estratégia poderia ser usa da para aumentar a produção de culturas assemelhadas. O conhecimento ajudará a orientar tanto o melhoramento clássico
quanto abordagens que aproveitam as tec nologias de edição de genoma.
Pesquisadores liderados pelo doutor Jiao Yuling descobriram que a edição de genes de um fator de transcrição (AP2/ERF - DUO1) pode melhorar em, no mínimo, 10% o rendimento de trigo (bitly.ws/thnL).
A espiga de trigo é composta de vários nós axiais, com uma espigueta na base de cada nó. A produtividade depende do nú mero de grãos da espiga. Que, por sua vez, está correlacionado com o número de es piguetas. Os pesquisadores usaram linhas mutantes de Brachypodium distachyon (bitly.ws/thoj) para investigar genes que regulam o número de espiguetas no trigo. No estudo, foi identificado um mutante de inserção de T-DNA denominado Bdduo1, que é responsável por gerar um número maior de espiguetas por espiga.
De posse da informação, os pesquisa dores editaram o gene do trigo usando a tecnologia CRISPR/Cas9 (bitly.ws/thoE).
Assim, foram obtidas plantas que, na parte média inferior das espigas, exibiam duas -três espiguetas em cada nó da raque. Imagens revelaram mais e maiores célu las nos primórdios de espiguetas basais do trigo mutante, em comparação com o tipo convencional, sugerindo que o gene regula a divisão celular. Esses genótipos produziram mais de 10% em relação aos convencionais.
Um grupo de cientistas liderados pelo doutor Shaobo Wei realizou uma análise comparativa de transcriptomas e metabo lomas de milho e arroz (bitly.ws/thpC). O estudo revelou um conjunto de 118 fatores de transcrição que podem atuar como re guladores da fotossíntese de plantas. Des ses, foram selecionados 13 genes ativados em plantas cultivadas em solo pobre em nitrogênio. Entre eles, cinco propiciaram que a planta absorvesse até 300% mais nitrogênio.
Contudo, o principal mérito do grupo foi identificar um fator de transcrição que regula a fotossíntese em arroz. Trata-se de um membro da família Dreb (Dehydration Responsive Element Binding), denominado OsDREB1C. A importância da descoberta é
que esse fator tem sua expressão induzida por alta intensidade luminosa e baixo teor de nitrogênio.
Para verificar o que ocorreria no cam po, os cientistas inseriram uma cópia extra do gene OsDREB1C em uma variedade de arroz chamada Nipponbare. Para usar co mo comparador, eliminaram o gene em outras plantas de arroz da mesma varie dade. No campo, as plantas sem o gene cresceram menos do que as plantas de controle, enquanto aquelas com cópias extras de OsDREB1C cresceram mais rápi do e tinham raízes mais longas.
E o mais importante: os rendimentos do arroz com cópia extra do gene foram 41% a 68% mais altos que na sua ausên cia. Além disso, a duração do ciclo foi mais curta, as plantas floresceram de 13 a 19 dias antes e acumularam maior biomassa no estágio de enchimento de grãos. Nos estudos preliminares com trigo, usando a mesma técnica, os aumentos de produti vidade variaram de 17% a 22%.
A História Universal, e de qualquer país individualmente, mostra que não há segredo para uma sociedade se de senvolver e enriquecer: são necessários investimentos polpudos e continuados em Educação e Ciência. É o que está ocorrendo, justamente agora, com Chi na e Coreia do Sul, que, em menos de 50 anos de investimento nessas áreas, saíram da pobreza estrutural para dispu tarem o protagonismo global em desen volvimento social e econômico.
Os estudos com sorgo foram financia dos com recursos da iniciativa privada (bi tly.ws/thpY) e do poder público (nrf.re.kr/ eng/main/). Os estudos com trigo e arroz foram financiados com recursos públicos (bitly.ws/thqp). As descobertas permiti rão retornos de milhares de vezes sobre o valor investido.
Fica o mote para o Brasil galgar degraus em desenvolvimento social e econômico.
Décio Luiz Gazzoni,
O autor é Engenheiro Agrônomo, pesqui sador da Embrapa e membro do Conselho Científico Agro Sustentável
Emrazão de seca em vários países e da guerra entre Rús sia e Ucrânia, há indicativos de ciclo de aperto no abas tecimento de alimentos e cotações acima da média histórica.
O Brasil está na fase de plantio. Há potencial de colher mais de 300 milhões de toneladas, frente a pouco mais de 270 mi lhões de toneladas colhidas anteriormente. Assim, o país ajuda o mundo a passar por uma crise menos grave.
Mas isso não afasta todos os problemas. O Brasil produz
A safrinha foi colhida. O plantio da safra de verão avança para o fi nal. E com boas condições de clima. Com isso, em pouco mais de cinco milhões de hectares, espera-se que o Brasil consiga colher algo perto de 30 milhões de toneladas na safra. A safrinha vai se definindo para a faixa de 87 milhões de toneladas. Assim, o País pode exportar mais de 35 milhões de toneladas. O consumo interno de ve beirar os 80 milhões de toneladas. Dessa forma, uma fatia dos estoques será consumida.
As exportações têm variado de R$ 90,00 a R$ 95,00 nos portos. O valor da venda ao mercado internacional seguirá ditando o interno. Até o co meço de setembro, o Brasil já tinha exportado 21 milhões de toneladas. Há fôlego para seguir forte no restan te do ano.
menos trigo que consome. Isso não irá mudar nos próximos anos. Há previsão de consumo de milho superior à produção. Isso também deve ocorre com o arroz.
Portanto, será importante para o mundo que o Brasil tenha sucesso na safra. E que venha na sequência uma excelente safrinha.
Tudo aponta para novo recorde de produção. O agronegócio brasileiro se consolida como o maior negócio do País.
Produtores plantam a todo vapor. Apostam em clima favorável. Houve chuvas no começo de setembro. Assim, mantém-se o potencial para recorde. Projeta-se plantio de 43 milhões de hec tares. Na safra passada foram 40,5 mi lhões. Pode-se atingir a produção de 150 milhões de toneladas (foram 124 milhões na anterior).
A soja é o maior produto da pauta de exportações do Brasil. Até o começo de setembro, gerou algo próximo de US$ 50 bilhões. O valor nos portos nas últimas se manas foi de R$ 190,00 a R$ 195,00.
O plantio do feijão recuou em razão dos custos. Alguns produtores optaram por soja. Assim, a oferta deve ser limitada e a demanda consistente.
As vendas estão baixas em razão do preço. Produtores falam em custos na ter
TRIGO - O mercado mostra tendência a recorde histórico de produção. Potencial entre nove e dez milhões de toneladas. O trigo é um produto de baixa liquidez interna. Os moinhos não formam grandes estoques. Portanto, os produtores devem planejar a comercialização. As melhores cotações ocorrem em fevereiro e março. Outubro e novembro são meses de colheita, quando a exportação é a melhor alternativa.
EUA - Colheita em andamento. Produtores reclamam de perdas decorrentes do clima. Indicativos: soja, 119 milhões de toneladas; milho, 354 milhões. Ambos abaixo do esperado. No milho, a queda pode chegar a 30 milhões de toneladas. Terão menos para exportar em 2023.
CHINA - Com a maior seca em décadas, haverá problemas graves na safra. O país deve atingir recorde de importação de alimentos, principalmente os grãos. Projeções: 100 milhões de
ceira safra ao redor de R$ 350,00. Mas o mercado estava pagando de R$ 280,00 a R$ 330,00. É a explicação para a baixa co mercialização. Contudo, há potencial para a melhora de preços.
O mercado do arroz está em ano fraco. Cotações têm oscilado no Rio Grande do Sul entre os R$ 70,00 e os R$ 80,00. O setor fala em custos de R$ 85,00. Muitos produ tores trocam de cultivo. Principalmente para a soja. A área plantada no Brasil deve cair para 1,45 milhão. A maior retração de ve ocorrer no Rio Grande do Sul. Pode cair 100 mil hectares. Se ocorrer, as cotações do arroz podem melhorar.
Exportações têm sido alternativa de liquidez. Estima-se, no fechamento da temporada, algo em torno de dois milhões de toneladas (base casca). Com indústrias abastecidas, tem sido a melhor alternativa para os produtores.
toneladas de soja; 20 milhões de milho; mais de dez milhões de trigo; e sete a dez milhões de arroz.
ARGENTINA - Plantio iniciando. Nas principais áreas, a seme adura ocorre em novembro e dezembro. Os riscos são grandes: custo dos insumos, escassez e impostos, principalmente. Em se tembro, o governo criou o "Dólar Soja". O produtor vendia com favorecimento cambial. Isso movimentou o mercado. A dúvida é sobre a manutenção dos valores cambiais. De qualquer modo, com os 33% de "retenciones", o plantio corre riscos. Projetam-se menos de 15 milhões de hectares. Produtores falam também em dificuldade para comprar diesel.
Vlamir Brandalizze Twitter@brandalizzecons www.brandalizzeconsulting.com.br Instagram BrandalizzeConsulting ou Vlamir Brandalizze

Pormuitos anos o solo vem sendo estudado por seus atributos físicos e químicos. Modernamente, passou a ser pesquisado com mais afinco sob o ponto de vista biológico. A cada dia que passa mais e mais vai se conhecendo que, além dos dois atributos acima, existe uma pujante vida sob a vegetação. Animais e micro-organismos formam um mundo vi brante e cheio de vida, com inúmeras co munidades que se organizam para exercer sinergicamente suas funções.
Cada vez mais se conhece o funda mental papel que os micro-organismos exercem para a vida na Terra. A dispo nibilidade de nutrientes para as plantas é, quase toda, intermediada por seres microscópicos que, aos bilhões, dispo nibilizam macro e micronutrientes que irão permitir elevadas e sustentáveis co lheitas através dos anos. A conservação da integridade dos solos, mantendo suas qualidades físicas, químicas e biológicas, entrou definitivamente na agenda da agricultura, seja em pequenas, médias ou grandes propriedades rurais. O plan tio direto, com a conservação de matéria orgânica e umidade, é uma das mais efi cazes ferramentas para dar mais vida ao solo, cirando um ambiente propício à ati vidade microbiana.
Mas há outro aspecto da microbiota que está sendo intensamente estudado e pesquisado, pois abre fronteiras infini tas para o aumento das colheitas de uma forma sustentável através dos anos. A in teração entre micro-organismos, a ativi dade conjunta e a comunicação entre os micro-organismos e as raízes das plantas geram inúmeros efeitos sobre as espé cies nativas ou cultivadas, o que abre um campo enorme para a identificação des ses mecanismos. E a intervenção humana pode transformar esses conhecimentos em tecnologias, à semelhança do que já se faz com a fixação biológica do nitrogênio, campo no qual um trabalho meticuloso e organizado criou os inoculantes, que ho je são utilizados largamente nos cultivos de soja, feijão e outras leguminosas, com

significativos aumentos de produtivida de e redução de custos para o agricultor, além de uma enorme contribuição para o meio ambiente.
A prospecção da microbiota nos di versos biomas brasileiros, riquíssimos em biodiversidade, vem identificando micro -organismos que já estão gerando novos produtos que aos poucos vão se incorpo rando à atividade agrícola. Hoje, já exis tem no mercado, além dos inoculantes tradicionais, produtos para solubilização do fósforo que se encontra imobilizado no solo e outros com bactérias que per mitem à planta tolerar curtos períodos de estresse hídrico, essas últimas isoladas de solos da caatinga.
Outros micro-organismos, coletados em solos da Amazônia, mais especifi camente em plantas de guaranazeiro, estão sendo testados com resultados promissores em milho e cana-de-açúcar, trazendo maior enraizamento, com todas as vantagens que isso proporciona para a planta, como maior absorção de água e nutrientes.
Também na Amazônia, onde a pala vra sustentabilidade tem um significado
todo especial, foi verificado que se pode cultivar o caupi (Vigna unguiculata) com menor dose de fertilizante nitrogenado. Sendo essa cultura altamente exigente em nitrogênio, a substituição do fertili zante nitrogenado pela inoculação com a bactéria fixadora traz uma excelente ferramenta, não só para uma maior eco nomia para o pequeno agricultor que vi ve naquela região, pois diminui o uso de um fertilizante que gera, desde sua pro dução até o uso na lavoura, cerca de dez quilos de gás do efeito estufa, enquanto que o uso de produto biológico tem uma emissão muito mais baixa. Falando-se em Amazônia, toda a prática agrícola naquele bioma deve levar em conta, com muita ênfase, a questão ambiental.
Ensaios conduzidos pela Embrapa Amazônia Ocidental mostraram que a uti lização de inoculante à base de Bradyrhi zobium levou a uma produção de grãos igual à adubação com 40kg de nitrogênio na forma de ureia. Como o caupi é uma das bases da alimentação para a popula ção do Norte e Nordeste e é cultivado em pequenas áreas, essa redução de custo na produção é de grande importância.
Outros microorganismos, coletados em solos da Amazônia, mais especificamente em plantas de guaranazeiro, estão sendo testados com resultados promissores em milho e cana-deaçúcar, trazendo maior enraizamento, com todas as vantagens que isso proporciona para a planta, como maior absorção de água e nutrientes
Desta forma, dentro do acelerado crescimento do uso de biológicos na agri cultura não só no Brasil, mas em todo o mundo, a imensa diversidade dos biomas brasileiros apresenta um campo imensu rável para a prospecção de micro-orga nismos que possam entrar no já extenso rol de produtos em uso na agricultura, trazendo benefícios para a sociedade co mo um todo, seja no aspecto econômi co, como na sustentabilidade de nossa agricultura.
As empresas da ANPII, sintonizadas com esse propósito, vêm desenvolven do, em seus laboratórios ou em conjunto com entidades de pesquisa, novos micro -organismos benéficos que possam gerar novos e mais eficientes produtos.
Solon Araujo, Consultor da ANPII Nicolas Braga Casarin, Assessor da ANPII

